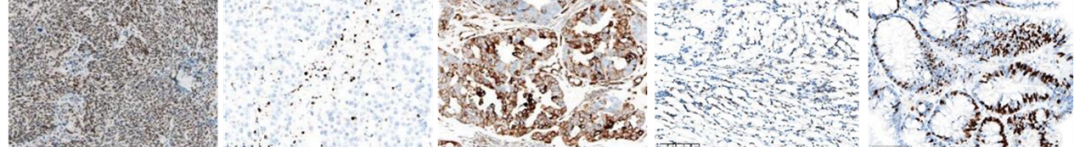

前言
近來CD276作為抗腫瘤生物藥物的新興靶點,吸引了廣泛的關注,這里我們總結梳理了CD276的背景知識,并開發(fā)了相應的免疫組化檢測方法,給大家做一個簡要的介紹。
CD276簡介
CD276,又名B7-H3,是免疫調節(jié)蛋白B7家族的膜蛋白成員。B7-H3在免疫系統(tǒng)中具有雙重作用,是一種新的免疫檢查點,其在腫瘤的發(fā)生發(fā)展中也起到了重要的作用,如促進腫瘤的遷移和侵襲,抗凋亡,促進細胞活力,化療耐藥性,上皮間質轉化等。

B7家族及其功能
CD276基因
CD276基因定位于15號染色體,包含7個外顯子和6個內含子,編碼316個氨基酸[1]。 人類CD276蛋白有兩種剪接異構體,分別為2IgB7H3和4IgB7H3。區(qū)別在于后者的胞外區(qū)為2個IgV、IgC的串聯重復結構。2IgB7H3存在膜上和可溶性兩種形式而4IgB7-H3由于無法被裂解而只有存在于膜上[2]。熙寧生物CD276抗體識別位點位于胞外區(qū)V1段,可同時識別CD276基因翻譯的兩個蛋白。

人類CD276結構示意圖[3]
CD276的表達與腫瘤發(fā)生發(fā)展的關系
多項研究證實,CD276在大多數正常組織中低表達,但在多種腫瘤組織中過表達。這使其成為一個非常有潛力的免疫治療靶點。


B7-H3在正常組織和部分腫瘤中的表達示例

B7-H3在各種人類實體瘤中的表達
CD276在腫瘤的發(fā)生發(fā)展中起到了重要的作用
CD276作為T細胞抑制分子來促進腫瘤的增殖和浸潤(盡管其早前被報導也可作為T細胞激活分子),其表達上調可促進腫瘤細胞的免疫逃逸,同時減少IFN-γ , TNF-α及其他細胞因子的分泌。有研究報導,CD276可促進腫瘤細胞對葡萄糖的攝取以及無氧條件下的糖酵解,也參與腫瘤細胞的轉移。針對肝癌的研究表明,CD276促進了癌細胞的EMT轉化,多項研究顯示CD276在腫瘤血管內皮細胞上表達,參與腫瘤血管生成,且不會在正常血管中表達[4]。
CD276的表達與患者預后
癌癥患者中更高水平的CD276表達往往與預后不良相關[2,5]。Mao等在128例非小細胞肺癌中評估了CD276表達與臨床病理參數及預后的關系。免疫組化染色結果顯示CD276在腫瘤細胞的胞膜和胞漿中表達,它的表達與淋巴結轉移、更高級別的TNM分期有關。共表達B7-H1和B7-H3(即CD276)的患者往往預后更差[6]。Yang等在一項56例接受一線EGFR激酶抑制劑治療的高級別肺腺癌研究中,通過免疫組化的方法檢測CD276的表達并對染色強度和陽性腫瘤細胞百分比進行了統(tǒng)計分析,結果顯示CD276的高表達與更短的PFS(無進展生存期)和OS(總生存期)顯著相關[7]。而Jung Hee Lee等針對透明細胞腎細胞癌的研究也表明CD276的表達與更短的PFS相關,說明CD276可作為透明細胞腎細胞癌獨立的預后指標[8]。

乳腺癌、卵巢癌、肺鱗癌、肝細胞癌及胃腺癌中,
CD276高表達與預后不良相關[5]
CD276相關藥物研究進展
目前以CD276為靶點的在研藥物已超40個,涉及單抗、雙抗、ADC、CAR-T等各個領域(如下圖所示)。

CD276靶點相關部分臨床試驗
MacroGenics開發(fā)的Enoblituzumab(MGA271)是一款人源化的抗CD276單抗,通過Fab端結合腫瘤細胞同時Fc端結合如NK細胞、單核巨噬細胞、中性粒細胞等效應細胞,觸發(fā)效應細胞殺傷靶細胞從而發(fā)揮抗腫瘤功能。I期臨床試驗顯示該藥物具有很好的耐受性,在惡性黑色素瘤、前列腺癌、膀胱癌、乳腺癌、腎透明細胞癌等多腫瘤類型中觀察到大于12周的疾病穩(wěn)定期和2%-69%的腫瘤縮小。在一項前列腺癌的II期新輔助治療試驗中,接受enoblituzumab用藥的患者相比未用藥的顯示出CD8陽性T細胞顯著增加[9]。
第一三共的DS-7300是將CD276特異的單抗與DNA拓撲異構酶I抑制劑偶連的ADC藥物,在一項針對高級別實體瘤患者的I/II期研究中顯示出較好的藥物耐受性及抗腫瘤效果,另一項針對經治的廣泛期小細胞肺癌的II期臨床試驗正在進行中。
MacroGenics公司的另一款藥物Orlotamab是一種靶向CD276和CD3的雙抗,通過促使T細胞重新定位來殺死CD276表達的腫瘤細胞。而由于一些安全原因,Orlotamab被FDA終止了研究[10]。
而在眾多藥物中,靶向CD276的CAR-T細胞療法占據了半壁江山。如博生吉醫(yī)藥的TAA06注射液,已于去年獲得了FDA授予的孤兒藥資格認定,其針對復發(fā)/難治神經母細胞瘤的國內I期臨床目前正在進行中。
CD276免疫組化檢測方法簡介
熙寧生物 | 精翰生物免疫組化實驗室已建立了成熟的CD276染色方法與判讀體系,適用肺癌、腸癌、食管癌等多個癌種,可快速用于CD276相關藥物開發(fā)過程中的入組檢測、探索性生物標志物檢測等。

CD276染色等級示意圖
(來自熙寧生物|精翰生物IHC實驗室)
肺癌

結直腸癌
食管癌

CD276在不同腫瘤上的染色
(熙寧生物 | 精翰生物免疫組化實驗室)
熙寧生物免疫組化實驗室
熙寧生物免疫組化實驗室擁有BenchMark Ultra,Dako Autostainer Link 48等國際公認的免疫組化染色平臺,遵從CAP和GCP體系要求,按照“合規(guī),精準,伴隨診斷”的理念,成功完成包括PD-L1、Claudin18.2、dMMR、TIM-3、TROP-2、AR等近200種靶標的免疫組化方法開發(fā)(部分結果如下圖所示),多種方法已獲得國內外權威機構的認可。


熙寧生物免疫組化實驗室(精翰生物)室間質評合格證書
GPC3
MAGE-A4
DLL3
CD276
NY-ESO-1

MSLN
PRAME
PD-1
CEACAM5
CD70

扁桃體
卵巢癌
扁桃體
結直腸癌
腎細胞癌
c-MET
AR
CCNE1
HIF-1a
p-SMAD2

肺癌
乳腺癌
卵巢癌
乳腺癌
腸癌
ATM
γ-H2A.X
STING
EZH2
pRb
卵巢癌
乳腺癌
卵巢癌
淋巴瘤
腸癌
CD39
CD73
Nectin-2
Nectin-4
TGF-beta

腸癌
扁桃體
睪丸
乳腺癌
肺癌
CK5
CK7
PVR
OX40
EpCAM

扁桃體
乳腺癌
胎盤
結腸癌
腎臟
對于客戶的伴隨診斷需求,我們篩選出了多株具有伴隨診斷開發(fā)價值的單克隆抗體并完成了前期的試劑盒開發(fā)。可隨時為廣大藥企客戶提供抗體篩選,方法學開發(fā),樣品檢測,伴隨診斷試劑盒開發(fā)等服務,歡迎致電咨詢。
參考文獻
| 2019天堂在线手机| 色诱视频网站免费观看| 国产亚洲精品久久久久丝瓜| 中文无码av毛片人妻免费| 亚洲国产货青视觉盛宴| 中文字乱码电影在线播放| 亚洲精品一区二区3| 99国产精品人妻无码免费| 中国日本韩国免费观看视频 | 无人区乱码1区2区3区网站| 337p日本欧洲亚洲大胆精品555588| 香蕉AV亚洲精品一区二区| 成人欧美一区二区三区A片| 99精品又大又爽又粗少妇毛片| 久久99精品国产麻豆婷婷洗澡| 不卡av一区二区在线观看| 麻豆画精品传媒2021一二三区| 久久久久久九九97精品中文无码| 99视频内射三四 | 亚洲AV成人无码久久精品A片| 欧美亚洲日本韩国免费网站| 人人人爽人人澡人人高潮| 《漂亮的保姆》5韩国电影| 性饥渴姓交HDSEX| 四虎最新地址通知www| 《丰满的女邻居》在线观看 | 黑人大JI巴太粗太长了A片| 免费全部黄A片免费播放| 色日韩在线视频全集| 国产嫖妓一区二区三区无码| 亚洲熟妇无码AV在线观看网址| 国产成熟妇人高潮A片| 18禁无遮挡羞羞污污污污免费 | 高清粉嫩无套内谢国语播放| 天天影视欲香欲色成人网| 国产午夜男女爽爽爽爽爽| 国产国拍精品AV在线观看| 亚洲AV人人爽人人澡| 国产成人A亚洲精V品无码| 性欧美13处14处破| 麻豆国产AV尤物网站尤物| 99热夜色精品三级免费观看 | 国产美女在线精品观看福利| 18禁欧美猛交XXXXX无码| 国产亚洲精品久久久久久一区二区| 蜜臀av性久久久久蜜臀aⅴ流畅| 日韩精品一区二区三区入口| 十八禁无码啪啪无遮挡网站 | 免费无码高潮又爽又刺激久久aⅤ| 国产毛多水多女人A片色情舞| 辽宁老熟女啪啪对白| 亚洲色婷婷婷婷五月| 亚洲高清91在线| 国产AV亚洲精品久久久久久小说| 久久精品秘一区二区三区美小说 | 日本三级视频在线2018| 女人高潮喷潮免费毛片| 182午夜国产精品福利| 久久草视频这里只精品99| 欧洲精品一卡2卡3卡4卡乱码| 亚洲AV成人无码久久精品A片| 国产91无码一区二区三区噜| 欧美国产日韩一区二区| 精品无人区一区二区三区蜜桃小说| WWW免费刺激无码又爽又色视频| 精品一区二卡三卡四卡分类| 日产区一线二线三AV| 国产美女精品a在线鸭王| 七月丁香五月婷婷首页| 国产69视频亚洲色欲色欲888www| 国产av福利久久精品涩爱| 波多野结衣一区二区| 天天摸夜夜摸摸到高潮| 日本妇人成熟免费中文字幕| 少妇无码吹潮久久精品AV| 中文字幕日韩人妻| 国产亚洲精品AAAA片小说| 国产精品久久久久久喷浆| WWW婷婷AV久久久影片| 亚洲国产精品无码久久久五月天| 五月色婷婷中文开心字幕| 国产免费无码成人A片在线观看 | 国产做爰又粗又大又爽动漫| 最新在线伦费观看中文| 一级婬片AAAAAAA密柚| 91网站久久国产精品| 色噜噜狠狠一区二区三区| 又黄又刺激又高潮的小说| 国产av无遮挡网站| 永久免费看MV网站入口亚洲| 高清色惰www日本午夜色视频| 日本国产一区在线观看| 国产片?V片永久免费观看| BBW.妇女被内射| 大肉大捧一进一出好爽视频MBA| 91精品久久久久久久久久小网站| 成人片在线观看 免费| 俄罗斯兽交XXXXX在线| 日本一区二区高清片片| 又大又粗又黄又刺激的免费视频 | 中文字幕亚洲无线码a| 囯产A片又粗又爽免费视频 | 福利导航第一福利导航| 精品人妻伦九区久久AAA片69 | 麻豆精产国品一二三产品区| 肉YIN荡公厕肉便调教车AC| 国产69精品久久久久久久久久久久| 麻豆国产人妻欲求不满谁演的| 亚洲熟女片嫩草影院| 国产3p一区二区三区| 91网站久久国产精品| 色欲久久精品AV无码| 边做边爱免费看视频| 久久久综合中文字幕久久| 成人久久18秘免费网站| 亚洲AV又黄又爽超级A片软件| 东北55熟妇与小伙啪啪| A片欧美乱妇高特黄AA片片| 亚洲欧美日韩国产中文| 韩国A片小视频在线看| 国产婬A片999片免费网站| 精品夜夜澡人妻无码AV| 岛国小视频在线观看| 午夜福利不卡在线视频| 亚洲精品无码成人A片在线漫画 | 影音先锋中文字幕人妻| 粉嫩精品一区二区三区在线观| 99无人区码一码二码三码| 少妇大荫蒂被巨大爽爽| 99精品成人无码A片观看金桔| 亚洲无人区码一码二码三码的特点| 日韩美女乱淫试看屁视频网站| 麻豆国产精品色欲AV亚洲三区| 老牛无码人妻精品1国产| ass少妇无码免费视频| 少妇真实被内射视频三四区| 国产又粗又猛又爽又黄A片漫画 | 一卡二卡三卡四卡无卡免费播放在线观看 | 成人免费AA片在线观看| 91成人国产麻豆一区二区| 中日韩AV亚洲高潮无码| 自拍 偷拍 亚洲 欧美 另类 | 久久免费视频精品在线| 2023国产福利在线| 国产精彩视频精品视频精品| 免费无码高潮又爽又刺激久久aⅤ| 色婷婷丁香A片区毛片区女人区| 中文字幕不卡一区| 高清国产不卡视频| 2020中文在线一区二区三区| 艾草在线精品视频播放| 永久免费看A片无码网站四虎 | 国产午夜精华精华精华婷 | 99久久精品免费看国产四区| 最近中文字幕MV在线视频2019| 国产精品特黄大片| 91人妻一区二区三区| 亚洲中国老头老太性hd| 一本大道一卡二卡三卡 视| 一级毛片免费视频| 97se亚洲综合自在线尤物| 又大又硬又粗做大爽A片| 婷婷激情五月AV在线观看| 狠狠躁日日躁夜夜躁2022麻豆 | 一女被二男吃奶A片视频| 国产成人va在线播放免费| 国产+日韩+欧美高清视频| 久久免费视频精品在线| 大象一区一品精区搬运机器 | 人妻体内谢精一区二区| 男女一边摸一边做爽爽的免费文字| 香蕉国产精视频在线观看| 少妇我被躁爽到高潮A片| VA在线看国产免费| 日本免费无码床戏视频| 成人做爰A片免费看网站漫画| 粗大猛烈进出身体高潮视频| 欧美国产亚洲18| 国产男人午夜视频在线观看| 国产亚洲成AV人片在线观黄桃| av在线1区2区| 少妇伦子伦精品无码| 美女视频黄a视频全免费网站色窝| J8又粗又硬又大又爽又长A片| 免费v片所有免费网站 | 成A人亚洲精V品无码樱花国产| 国产农村熟妇videos| 国产不卡成人av| 污到你湿的动态图片gif| 亚洲 第一区 欧美 日韩| 国产成人A亚洲精V品无码| 国产中文欧美日韩在线| 麻豆精选果冻传媒1.0.2| 女人自熨全过程直播| 亚洲精品少妇久久久久久海角社区| 久99久热只有精品国产99| 91无码真人中文字幕| 啊用力嗯轻一点男同软件| 午夜人妻理论片天堂影院| 奶水少妇被狂躁c到高潮喷水麻豆| 国产综合亚洲日韩| 小骚妇下面水多要插视频| 欧洲欧美人成视频在线| 亚洲精品无码成人A片在| 欧美mv日韩mv国产mv网站| av在线1区2区| 出轨人妻无套激情内射| 中文字幕美人妻亅U乚一596| 亚洲巨乳日本无码一二三区| 美女内射毛片在线看| 又大又粗又爽免费视频A片| 久久精品免费人成人A片| 出轨人妻无套激情内射| 国产精品无码成人午夜电影 | AV午夜午夜快憣免费观看| 日本VA欧美VA精品发布| 国产特级毛片??????毛片| 抖音WWW视频在线观看| 国产人妻精品久久久久久很牛| 亚洲国产精品成人午夜在线观香| 欧美成人做爰高潮片免费看借种| 黄大色黄大片女爽一次| 精品无人区卡卡二卡三乱码| 国产一a毛一a毛A免费看图 | 3d白洁妇珍藏版漫画第一章| 精品无码一区二区的天堂| 亚洲国产精品无码久久久久久久久| 精品久久久久久久久久久下载 | 欧美日韩一级内射可以观看的视频| J8又粗又硬又大又爽又长A片| 国产AV天堂无码一区二区三区 | 两个奶被揉到高潮视频| 国产福利视频在线精品| 免费日韩中文字幕高清电影| 欧美AAAAAABBBBB| 成人大尺度做爰视频网站| 国产精品国产三级国产有无| 日韩在线免费观看污污视频| 日韩国产精品欧美一区二区| 日韩亚洲v无码一区二区不卡| 久久日产一线二线三线SUV| 亚洲男人97色综合久久久| 成年人免费看的视频| 亚洲精品无码成人A片在线漫画| 欧美乱码一卡5卡6卡新区| 成人做爰片免费网站| 日韩国产成人无码AV毛片蜜柚| 日韩国产成人无码AV毛片蜜柚| 蜜桃成人无码18网站在线观看| 国产五月色婷婷六月丁香视频 | 国产精品久久久久一区二区三区共| 少妇搡BBBB搡BBBB毛多多 | 色欲久久精品AV无码| 亚洲熟女乱色综合一区小说| 国产剧情麻豆刘玥视频| 麻花豆传媒剧国产MV入口| jiZZ亚洲中国日本jiZZ | 一女被二男吃奶A片视频| 日本人妻伦在线中文字幕| 无人区码卡二卡1卡2卡三卡| 91在线欧美日韩精品| 女人高潮喷潮免费毛片| 91黑料精品国产| 一本av高清一区二区三区| 欧美人zoxxxx另类| 欧美一级淫荡免费观看| 久久久精品日韩免费观看| 欧美躁天天躁无码中文字| 最近中文字幕国语免费av| 老头把我添高潮了A片故事| 欧洲无人区卡一卡二卡三 | 无码人妻一区二区三区在线视频 | 国产人妻爽到欲仙欲死| 俄罗斯粗大猛烈18P| 亚洲 欧美 变态 卡通 自拍| 少妇被猛烈进入A片| 国产精品久久久久久久久久久久久久久 | 恩教官不要好大好硬好爽小雪| 国产福利小视频尤物98| 四川少妇WBB槡BBBB搡BBBB| 羞羞视频网站在线观看18岁无遮挡| 2222av.com| 免费无码又爽又刺激A片软| av网站尤物在线观看| 亚洲日韩精品一二三四区| 午夜大片视频在线观看| 国产呦精品一区二区三区下载| 亚洲国产精品一区二区玖玖| 蜜臀国产一区二区三区无码A片 | (凹凸)最新毛片婷婷99精品视频 | 亚洲精品毛A片久久久爽| 无码AV免费精品一区二区三区| 欧一美一性一交一免一费一H一D | 青青五月天久久大一香蕉| 麻豆视传媒官方网站入口进入| 日韩精品一区二区三区欲色AV| 亚洲伊人成色综合网| 国产精品人妻黑人借宿电影| 青青五月天久久大一香蕉| 2024中文字幕在线高清| 蜜色欲多人AV久久无码| 91福利华人在线观看| 麻豆国产人妻欲求不满谁演的 | 久久九九少妇免费看A片| 99精品人人做人人综合试看| 波多野中文字幕一区免费 | 91手机在线视频免费播放| 最近更新中文字幕第一页| 亚洲AV永久无码天美传媒潘金莲| 亚洲熟女av综合网| 国产AA久久大片日本无码| 国产日韩?v免费观看| 东北美女野外bbwbbw免费| 精品乱码一二三四区别 | 午夜成人理论片A片AAA图片| 99精彩视频在线观看| www.ooxx99.com| 亚洲精品AV无码喷奶水糖心| 亚洲A片无码成人精品区| 日本无码毛片久久久九色综合| 妓女嫖客叫床粗话对白| 波多野结衣巨乳女教师6| 国内精品久久久久久久小说| 亚洲精品一区二区二二三区| 亚洲日本久久久午夜精品| se01在线看片| 看国产一级特黄大片在线一| 日韩经典AV在线观看| 极品JK小仙女自慰喷水牛牛影视| 97在线看午夜福利| 欧美乱妇欲仙欲死视频免费 | 67194成是人免费网站| 亚洲精品久久AV无码麻小说| 轻点大JI巴太粗太长了A片| 无码内射成人免费喷射| 强壮公让我高潮八次苏晴| 爆乳JUFD492汗だく肉感| 国产福利小视频尤物98| 爆乳熟妇一区二区三区霸乳| 亚洲AV成人影视综合网| 亚洲无码精品在线观看| 日本无码一二三区别免费| 9丨九色丨国产人妻一区二区| 国产v综合v亚洲欧美| 麻豆精产国品一二三产品区| 青青小草国产在线播放| 天天天天噜在线视频| 国产乱人对白A片麻豆| 99精品国产亚洲| JIZZJIZZ少妇亚洲水多| 日韩精品色情AV无码一区| 91亚洲国产第一精品| 国产免费无码又爽又刺激A片动漫 天堂一日韩中文字幕 | 中文字幕亚洲综合小综合在线 | 欧美日韩精品一区二区三区高清视频| 国产电影无码午夜在线播放| 国模国产精品嫩模大尺度 | 伊人 在线视频一本道| 99精品成人无码A片| 鲁大师在线看片在线| 日韩人体做爰大胆337P| 国产v综合v亚洲欧美| 91久久精品一区二区别| 好爽插到我子宫了高清在线| 欧美视频一区二区三区| 国产精品日本无码久久一老A | 久久久久高清视频中文字幕 | 秘密列车动漫在线观看| 三人弄的我一夜高潮A片| 欧美日韩一区二区三区| 久爱成欢视频在线观看| 夜来香AV在线观看| 成年人免费看的视频| 日本xxxxxxx69xx| 女人囗交吞精口视频| 香蕉AV亚洲精品一区二区| 人妻熟女一二三区夜夜爱| 2021最新亚洲精品无码 | 国产真实乱人偷精品人妻69| 精品无人乱码一区二区三区无限看| 少妇被猛烈进入A片| 麻豆色情少妇传媒AV一| 国产99热在线观看| 国99精品无码一区二区三区| 国偷自产AV一区二区三区健身房| 高清无码日本一区二区| 国产精品美女自在线观看免费| 黑人强伦姧人妻日韩那庞大的| 萌白酱17分钟视频| 国产91精品看黄网站在线观看| 91久久人澡人妻人人澡人人爽| 黑人搡BBBBB搡BBBBB| 办公室的秘密赵雪晴第11章| 又硬又粗进去好疼A片麻豆| 久久97久久97精品免视看| 女人爽到高潮潮喷叫床69| 少妇被又大又粗又爽毛片久久黑人| 精品国产自在97香蕉| 强伦少妇A片视频| 色婷婷色综合缴情网站| 日韩在线视频www色| 蜜月a 免费一区二区三区| 男女性杂交内射妇女BBWXZ| 欧美黑人又大又粗毛片| 亚洲国产另类久久久精品黑人| 亚洲国产精品一区二区玖玖| 国产做A爱片久久毛片A片高清| 一本一道AV一区二区三区| 欧美激情一区二区三区四区| 狠狠躁日日躁夜夜躁A片55| 成a人v在线观看视频| 成人无码A片视频播放| 国产精品青青在线麻豆| 亚洲av无码专区亚洲av影音先锋| 欧美欧美成年人午夜视频| 日韩精品在线观看国产一级二级在线| 国产精品视频一区二区三区不卡| 老牛视频国产一区在线观看| 狠狠色综合婷婷网| 亚洲精品无码久久久久苍井空国产| 又色又爽的无遮挡免费网址| 7777色鬼XXXX欧美色妇 | 北条麻妃视频在线| 日本熟妇浓密毛毛多A片| 国产亚洲精品久久久久久禁果TV| 国产成人tv视频在线观看| 在线观看中文字幕不卡二区| 第一区第一视频中文字幕| 久久久乱码精品亚洲日韩| 久久tv中文字幕首页| 最近高清中文在线国语视频| av网站免费线看精品| 91成人免费观看网站| 粉嫩小又紧水又多A片| 蜜臀在线观看免费网址| 日本一区二区高清片片| 欧美黑人一级爽快片婬片高清| 国产亚洲精品久久久网站好莱| 日本国产一区在线观看| 性XX动漫鸣免费观看在线| 国产不卡av免费在线观看| 亚洲AV久久无码高潮喷水| 天天躁日日躁狼狼超碰97| 日本人妻中文字幕有码在线视频观看视频 | 国产精品久久人妻拍拍水牛影视| 很黄的吸乳A片三女一男| 国产伦精品一区二区三区免费肉| 成人国产三级在线播放| 99精品国产自产在线观看| 成年女人免费视频播放7777 | 一级一级特黄女人精品毛片视频| 2019最新国产不卡a国内2018| 国产喂奶挤奶一区二区三区| 中文字幕福利视频在线一区| 国产亚洲999精品AA片在线爽| 免费观看黄A片在线观看| 九九99亚洲精品久久久久| AWWW在线天堂BD资源在线| 狠狠躁日日躁夜夜躁A片55| 亚洲精品久久久久久中女字幕| 爽爽精品DVD蜜桃成熟时电影院| 91免费版视频网站观看入口 | 高清亚洲精品一区二区三区| 91在线免费观看网站| 国产色无码视频在线观看| 精品丰满人妻AV久久久| 男女激情无遮挡免费视频| WUYUETIANDINGXIANG| 2019最新国产不卡a国内2018| 国产丰满老熟妇乱XXX| 国产精品爱久久久久久久小说| 亚洲天堂av一本道无码| 99国产成人精品在线观看| 亚洲精品爆乳一区二区| 最近最新MV中文字幕国语免费| 成年女人免费视频播放7777 | 欧美又大又粗AAA片免费看| 先锋影音av资源站av| 国产h片在线播放网站 | 国产超碰人人做人人爱| 拍拍拍30分钟大叫不停在线观看| 欧美又粗又深又猛又爽A片| 成人A片产无码免费视频软件| 日产精品一卡2卡三卡四| 精品亚洲国产成AV人片传媒| 老头舔女荫道口视频| 奴色虐aV一区二区三区| 欧美黑人性受XXXX精品| 色情A片成人网站免费看视频| 国产又色又爽又刺激在线播放| 国产五月色婷婷六月丁香视频 | 四川少妇WBBBB搡BBBB嗓| 成人亚洲A片V一区二区三区蜜月 | 少妇寂寞被按摩师| 久久99国产精品二区不卡| 欧美特级特黄AAAAA片| 成人a∨专区精品无码国产| 成人免费A片XxX视频流奶| 国产中文欧美日韩在线| 日日摸夜夜添无码AVA片| 天堂最新版资源网日本| 久久久久亚洲视频| 免费乱理伦片在线观看2020| 成人国产精品免费视频观看| 成人午夜做爰高潮片免费吸气 | 日本一本二本三本区视频| 国产熟睡乱子伦视频在线观看| 日本高清一区免费中文视频| 最近中文字幕MV在线视频2019| 成片一卡二卡三卡观看| 欧美日韩一区区三区四区| 大香伊在人线一道本| 91精品中文字幕一区二区三区 | 亚洲精品成人无码A片在线| 欧美精品无码一区二区三区下载 | 亚洲精品区免费观看av| 国产乱码一卡二卡3卡4| 少妇被躁爽到高潮无码A片小说| 最近中文字幕在线资源3| 成人无码精品免费视频在线观看| 色YEYE在线视频观看网站| 高清国产不卡视频| 欧美精品1区2区3区| www.834.com.成人片| 麻豆精产国品一二三产| 一本道高清不卡v免费费| 成年午夜免费韩国做受视频| 性无码一区二区三区无码免费| 国产精品久久久久久人妻精品流| 岛国色情A片无码视频免费看 | japanesevideo喷潮| 宅男在线永久免费观看网直播 | 久久久久久久999| 蜜臀在线观看免费网址| 香蕉97人妻免费碰碰碰| 免费无码一区二区三区A片下载| 白嫩无码人妻丰满熟妇啪啪区百度 | 免费无码又黄又爽又刺激| 欧美成人猛片AAAAAAA| 欧美人与动牲交ZOOZ乌克兰| 白天躁晚上躁天天躁2022| JIZZJIZZ少妇亚洲水多| 美女网站在线观看视频18| 久就热视频精品免费99| 亚洲欧美国产日韩综合| 亚洲乱码卡一卡二卡新区豆| 2019最新福利天堂视频92视频| 成人亚洲A片V一区二区三区日本| 日本黄色成年人免费观看| 精品乱码一二三四区别| 黄页网站18以下勿看免费 | 成年人免费网站视频| 免费乱理伦片在线观看夜| 一卡二卡三卡四卡无卡免费播放在线观看 | 高清粉嫩无套内谢国语播放 | 欧洲精品卡1区2卡三卡| 免费无码又爽又刺激高潮的动态图| 啪啪激情婷婷久久婷婷色五月| 日本老头4569gay| 春暖花开 网友自拍区| 欧美躁天天躁无码中文字| 被窝影院午夜看片爽爽| 欧美一级太片xxxx| 安徽妇搡BBBB搡BBBB| 亚洲多毛妓女毛茸茸的| 国产女主播在线观看一区| 色噜噜AV亚洲色一区二区| 狂躁女人屁眼爽出白浆的视频网站| 蜜桃人妻一区二区三区欧美| 粗大的内捧猛烈进出少妇在线播放| 久在线视频reer6| 91麻豆国产自产精品| 99视频免费在线| 香蕉AV777XXX色综合一区| 亚洲丰满熟妇XXXX性A片| 久久国产精品激情对白| 精品自拍农村熟女少妇图片| 一夜七次郎免费线路www2| 一本道的mv中文字幕| 91麻豆国产免费| 中文字幕A片视频一区二区| 98久久无码一区人妻A片蜜| 五月色婷婷中文开心字幕| 豪妇荡乳1一5杨贵妃| 98色精品视频在线| 那种视频在线观看亚洲| 亚洲福利无码一区| 欧美性A片又大又长| 亚洲国产熟妇无码一区二区69| 色欲久久精品AV无码| 欧美肉大捧一进一出免费视频| 四色成人A片视频在线看| 波多久久亚洲精品AV无码| 在线亚洲午夜片AV大片| 久久人人超碰精品caoporen| 一级婬片AAAAAAA密柚| 亚洲精品久久久久久动漫| 韩漫污污污无遮免费| 中文字幕亚洲综合小综合在线| 熟睡进入xxxxhd| 国产SUV精品一区二区| 成年人免费网站视频| 内射精品无码中文字幕| 黑人强辱丰满的人妻熟女| 国产高中生三级视频| 日产乱码一二三区别免费麻豆| 成人国产在线观看| 蜜臀国产一区二区三区无码A片| 国产av无码专区亚洲草草| 国产成人精品亚洲精品一区色欲| 国产开嫩苞视频在线观看 | 性欧美13处14处破| 一区二区三区四区亚洲国产| а√天堂中文最新版| 免费无码又爽又刺激A片软| 午夜肉体高潮免费毛片| 18禁欧美猛交XXXXX无码| 亚洲和欧洲一码二码区别7777| 国产开嫩苞视频在线观看| 国产亚洲AV片在线观看16女人| 激情内射日本一区二区三区| 吖v在线免费高清国语| 麻豆传煤APP免费网站网址高三 | 成人亚洲精品久久久久| 亚洲精品AV无码喷奶水糖心| 国产精品顶级A片无码久久久| WWW夜片内射视频日韩精品成人| 青青在线经典视频在线| 日本1卡2卡3卡4卡| 和老外3p爽粗大免费视频 | 亚洲精品久久黄大片| 麻豆视传媒app官方下载| 国产精品色无码AV在线观看| 国产精品久久久久无码AV1 | 爱啪网亚洲第一福利网站 | 99操在线观看国产视频| 91成人在线观看喷潮教学| 久久成人做爰电影图片| 寡妇张开腿让黑人捅爽| 大黑鳮巴视频欧美| 做爰高潮A片视频35分钟| 辽宁老熟女高潮狂叫视频| 绑起被各种性器折磨的漫画| 欧美日日夜夜撸影院| 日本动漫爆乳H无码黄漫动| 亚洲 小说 欧美 中文 在线| 久久亚洲精品AV成人无| 天天日天天日天天爽天天射| 国产91专区视频在线观看| 成片一卡二卡三卡观看| 九九久久精品国产免费看小说 | 亚洲色婷婷婷婷五月| 精品日韩一卡2卡三卡4卡乱码| 国产成人无码AA片免费看| 第一区第一视频中文字幕| 日韩无码一区二区三区| 99精品成人一区二区三区在线| 天堂va欧美va亚洲va国产| 毛片里面女的下面喷水| 欧美精品3atv一区二区三区| 国产特黄级AAAAA片免| 玩50岁四川熟女A片| 欧美成人精品一级A片奶水小说 | 91丨国产丨精品丨丝袜| 欧美日韩精品一区二区三区激情在线| 91中文字幕国产| 国产亚洲精品久久久一区| 97亚洲熟妇自偷自拍另类图片| 按摩做爰A片在线播放| 国产精品色无码AV在线观看| 人妻内射一区二区在线视频| 免费又硬又爽又黄又免费| 欧美性生交XXXXX无码专区| 宅男在线永久免费观看网直播 | 老司机求福利网址2017| 精品噜噜噜噜久久久久久久| 玩弄少妇高潮A片XXX| 日本二本道dvd视频| 国产重口老太和小伙A片| 色欲AV亚洲午夜精品无码电影| 亚洲美腿丝袜无码专区| 高清免费在线毛片| 国产欧美三级在线观看| 国产女人夜夜春夜夜爽免费看| 国产SUV精品一区二区| 丰满老熟女一级AA片色欲| www.83156.com| 日韩另类精品专区在线视频| 国产二级一片内射视频播放| 91黑料精品国产| 扒开腿cao烂你小sao货| www.夜夜撸.com| 国产不卡一区二区免费视频| 天堂一日韩中文字幕| 亚洲欧美另类制服| 久久免费看少妇高潮A片特无毒| av手机看片免费中文字幕| 人人妻精品视频免费| 91精品中文字幕一区二区三区 | 小草久久人热国产| 日本少妇BBW丰满做爰图片| 未满十八岁成年禁止观看亚洲天堂 | 宅男精品一区二区视频| 日韩内射美女片在线观看网站| 欧美成人精品一区二区综合A片| 国产高清无码免费a视频| 国产高清色情在线观看APP| 欧美精品1区2区3区| 黄色无码在线观看快操我| 精品卡1卡二卡三卡乱码| av中文字幕观看| 国产成人久久精品AV| 99国产精品视频免费观看一公开| 午夜成人理论片A片AAA图片| 男人天堂影院WWW94| 波多野中文字幕一区免费| 亚洲精品久久久无码AV片软件| 不小心进了岳坶的身体| 色综合欧美总和色| 丰满熟女人妻一区二区三| 亚洲AV无码国产精品色字幕综合| 亚洲AV无码成人啪啪| 国产精品一区二区不卡蜜臀在线 | 久草在线草a免费线看| 国产ZLJZLJZLJZLJ| 亚洲美腿丝袜无码专区| 小明日韩在线看看永久区域| 亚洲一区二区无码偷拍| 中文字幕无码A片久久| 俄罗斯兽交XXXXX在线| 国产在视频视频2019| 国模大尺度炮交视频免费看| 国产精品亚洲精品久久精品| 女女女女BBBBBB毛片视频| 色欲综合视频天天天| 国产91专区视频在线观看| 国产精品熟女高潮无套| 真人性23式(动)| 一级一级特黄女人精品毛片视频| chinese国产hdsex水滴| АⅤ天堂 中文在线| 嗯嗯鲁我们不生产av我们只是| 亚洲精品做爰无码片麻豆| 色偷偷超碰av男人天堂| 男人猛躁进女人的毛片A片| 亚洲午夜精品一区二| XXX波多野结衣苍井空| 欧美日本国产VA高清CABAL| 国产一级片内射视频蘑菇视频| 亚洲日韩国产成网在线观看| 中文字幕在线观看无码| 欧美阿v视频在线大全| 亚洲欧美偷拍综合图区| 久久免费视频精品在线| 性一交一乱一能一八一片| 狠狠cao日日穞夜夜穞视频图| 51无人区码一码二码| 免费一级无码婬片A片AAA| 精品久久无码人妻人伦Av| 99精品免费久久久久久久久日本| 北京少妇和黑人久精品| 嗯嗯鲁我们不生产av我们只是| 亚洲精品久久AV无码麻小说| 鲁大师在线看片在线播放| 国产免费看又黄又大又污的胸| 欧洲亚洲一区二区三区导航| 久久九九少妇免费看A片| 国产亚洲精品久久久性色情软件| 久久va成人高潮喷潮| 又黄又大又猛的A片| 真实国产熟女人妻AV17P| 亚洲欧美精品SUV苍井优| 国产亚洲精品久久久久久白晶晶| 亚洲免费观看福利视频| 91手机视频在线| 羞羞视频网站在线观看18岁无遮挡 | 国产精品久久久久久久蜜臀宾利 | 四川少妇WBBBB搡BBBB嗓| 韩漫污污污无遮免费| 搡女人真爽免费视频网站 | 国产欧美日韩精品一二三区 | 国产精品久久久久无码AV1| 成 人 黄 色 免费 网站无毒 | 99在线视频观看| 国语两人做人爱费视频| a v 在线视频 亚洲免费| 亚洲国产久久免费| 精品无码国产在线观看| 亚洲 欧美 动漫 中字 视频| 色偷偷超碰av人人做人人爽| 国产伦精品一区二区三区免费肉| 妺妺窝人体色WWW在线播放婚闹| 亚洲AV无码乱码国产一区二区 | 国产成人久久精品AV| 欧美又爽又大又黄A片| 亚洲国产一卡2卡3卡4卡5公司| 免费日韩中文字幕高清电影| 亚洲精品无AMM毛片| 国产一性一交一伦一A片| 无套内谢少妇高潮免费| 动漫美女禁处受辱图| 5566中文字幕永久| 麻豆果冻传媒2021精品传媒一区下载| 调教小鲜肉灌肠GV捆绑| 日本乱妇18日本乱妇18p| 国产精品顶级A片无码久久久| 亚洲福利无码一区| 啊轻点灬大JI巴太粗A片| 亚洲一区欧洲一区| 日本一本二本三本区视频| 美女脱内衣18禁免费久久久| 嗯啊开小嫩苞HHH...嗯啊| 97人妻人人揉人人澡人人爽国产| 日韩精品午夜视频一区二区三区| 92看看福利午夜影院| 日韩欧美国产一区啊| 少妇大乳妓女毛片A片| 国语两人做人爱费视频| 捆绑白丝粉色JK震动捧喷白浆| 91九色视频在线观看| 日本久久久WWW成人免费毛片丨 | R男女牲交45分钟A片 | 亚州免费A片无码区A片| 麻豆精产国品一二三产区区| 少妇WWWB搡BBB搡BBB| 在线中文新版最新版在线| 国产熟妇乱子伦hd| 99视频这里只有精品国产| 国产精品亚洲综合一区二区三区| 欧美午夜艳片欧美精品| 亚洲AV久久无码高潮喷水| 国产成人18黄网站白丝 | 美女被后入在线视频网站| 无码成人一区二区三区入厕偷拍| 黄页网址大全免费观看美女| 亚洲精品无AMM毛片| IJZZIJZZIJZZ教师水多| 免费无码高潮又爽又刺激久久aⅤ| 国产又色又爽又黄的免费站| 国产又黄又爽又刺激的免费网址| aaaa黄百度影音| 青青草a免费线观a| 国产精品久久久久久喷浆| 日韩无码一区二区三区| 欧美成人午夜精品久久久| 国产寡妇乱婬一区二区三区| 色欲国产麻豆精品AV免费| 亚洲天堂在线观看视频| 国产专区_爽死777| 老司机求福利网址2017| 亚洲精品久久久久久中女字幕| 国产天堂网一区二区三区| 性XX动漫鸣免费观看在线| 丁香婷婷六月综合交清| 欧美精品九九99久久在观看| 国产传媒麻豆剧精品AV| 伊人 在线视频一本道| 美女裸身无档视频免费| 中文字幕亚洲综合小综合在线| 色老头色老太aaabbb| 丁香六月婷婷色综合| 任你躁国语自产一区在| 西西人体做爰大胆| 亚洲国产货青视觉盛宴| 国产免费中文字幕?v在线| 午夜人妻理论片天堂影院| 四虎影视库免费永久视频| 大陆久久久久久久免费视频| 国产真人一级A爱做片免费看女人| 四虎影视库免费永久视频| 富婆偷人对白在线观看| 黄片大全免费在线观看| 半夜摸妺妺乳C起来好疼| 国产超碰人人做人人爱| 中文字幕亚洲无线码a| 啊灬啊灬啊灬快灬深草莓视频| 国产精品成人无码A片免费网址| jk制服白丝袜看内内18禁| 国产精品美女久久久久AV福利| 99视频内射三四 | Julia爆乳无码AⅤ一区二区| 少妇挑战3个黑人惨叫4P国语| 日韩乱码卡1卡2卡三卡四卡| 在线精品一卡乱码免费| 四川少妇WBB槡BBBB搡BBBB| 男人猛躁进女人的毛片A片| 免费一级A片高潮6次| 国产亚洲精品自在久久77婷婷| 巨爆乳肉感一区二区三区视频| 蜜臀AV99无码精品国产专区 | 亚洲成色7777777久久| 欧美大屁股熟妇BBBXXX| 99久久无码一区人妻A片红豆| 高清色惰www日本午夜色视频 | 成人国产三级在线播放| 麻豆国产精品色欲AV亚洲三区| 国产成人久久精品AV| 午夜神马福利电影不卡| 激情内射日本一区二区三区| 日韩A片无码一区二区五区电影| 日本人强伦姧人妻A片| 精品国产一区二区三区AV傅贞怡| 亚洲A∨成人一区影片在线观看| 高清一卡二卡三卡四卡免费观在线 | A阿V天堂免费无码专区| 强奷乱码欧妇女中文字幕熟女| 又色又爽的无遮挡免费网址| 91中文字幕亚洲| 成品片a免人看免费| 成人区精品一区二区不卡AV免费| 国产经典噜噜在线无码一二三区| 成人黄色视频91| 日韩一区二区视频在线观看| 亚洲精品AV无码喷奶水糖心| 一个人看视频的www片直播| av日韩精品一区| 最近中文国语字幕在线播放视频| 人妻满熟妇AV无码区国产| 久久久这里只有免费精品2018| 在线观看黄页网站大全电影天堂| 国产成人盗摄在线视频| 91精品中文字幕a| 成年网站免费视频A在线双飞| 极品吹潮视频大喷潮tv| 肉YIN荡公厕肉便调教车AC| jk制服白丝袜看内内18禁| 偷偷与邻居做爰完整视频| 无码内射成人免费喷射| SE网站在线观看免费视频| 又紧又大又长又粗视频社区在线| 国产又色又爽又刺激在线播放| 国产精品久久久久久久蜜臀宾利 | 欧洲亚洲精品A片久久99果冻| 免费乱理伦片在线观看2020| 国产乱码精品一区三上| 久久国产主播福利在线 | 高清自拍亚洲精品二区| 国产乱对白刺激视频| 福利导航第一福利导航| 麻豆免费观看高清完整视频在线| 成年人视频日本大香蕉久久| 欧美日日夜夜撸影院| 久久久久久久999| 国产大尺度吃奶无遮无挡| 亚洲无码精品在线观看| 国产v综合v亚洲欧美| 蜜桃在线码无精品秘入口九色 | 中文字幕一区二区区免| 国产重口老太和小伙A片| 一级一级特黄女人精品毛片视频| 香蕉一级婬片A片久久精| 丁香蜜桃综合cb| 色婷婷欧美在线播放内射| 少妇性色午夜婬片AAA片软件| 无码专区亚洲综合另| 高清无码视频免费观看| 中文字幕日韩人妻| 影音先锋资源站男人网| 男人J桶进女人下部无遮挡A片| 公与我做爽了A片视频| 国产人在线成免费视频| 亚洲精品无码成人A片在线虐C| 美女脱内衣18禁免费久久久| 揉同学母亲巨乳巨乳先锋影音| 亚洲 小说 欧美 中文 在线| 国产不卡一区二区免费视频| 欧洲亚洲一区二区三区导航| 成人亚洲A片V一区二区三区蜜月 | 久久久久久久综合狠狠综合| 成人亚洲A片V一区二区三区蜜月 | 亚洲AV无码乱码国产一区二区| 欧美精品区在线播放| 久久亚洲综合精品国产99| 日本1卡2卡3卡4卡| 欧美一级淫荡免费观看| 高潮无遮挡成人A片在线看| 精品一卡2卡三卡4卡乱码免费| 中文日产幕无线码一区2021 | 免费看YYYY片视频软件| 麻豆AV无码精品一区二区| 久久99国产综合精品免费| 亚洲巨乳巨臀在线一区二区BBW | 亚洲精品久久久久一区二区三区| 欧美变态另类残忍视频| 成人国产色情无码永久免费软件| 日本青青草三级在线| 无码精品A片一区二区电影在线| 国产成人免费爽爽爽视频| 五十路近親相姦中出し親子| 正在播放高清无码国产| (愛妃視頻)欧美日韩国产这里只有精品 | 打光PG打到红过程| 日韩在线视频www色| 亚洲一卡2卡3卡4卡在线新区| 午夜福利不卡在线视频| 精品动漫视频一区二区三区四区播放网站| 最新国产一二三区无码| 日韩欧美成人免费中文字幕| 日本高清不卡网站免费| 国产强被迫伦姧在线观| 国产天美三级网站| 久久HEZYO久综合亚洲色| 麻豆果冻视频传媒APP下载| 国产灬性灬淫…乱…视频…| 小sao货叫腿张开我cao死你| 亚洲精品无码久久久久苍井空国产| 免费在线观看a级毛片| 一本不卡视频在线久| 中文字幕理伦午夜福利片| 国99精品无码一区二区三区| 超碰97人人做人人爱亚洲尤物| 香蕉国产在线观看免费永久| 极品吹潮视频大喷潮tv| 无码人妻精品一二三区免费| 亚洲国产精品素人在线观看| 久久视频在线视频观看 99| 成年免费大片黄在看| 国产亚洲精品久久无码小说| 国产精品久久久久久久久久久久久久 | 免费无码又爽又刺激A片软| 成人欧美一区二区三区黑人免费| 国产色婷婷亚洲99精品小说| 一本av高清一区二区三区| 成片一卡二卡三卡观看| 好硬啊进去太深了A片| 成人a∨专区精品无码国产| 在线观看的a站 最新| 欧美黑人性受XXXX精品| 亚洲产国偷V产偷V自拍色情| 91麻豆国产免费| 日本一卡2卡3卡4卡免费观看 | 在线看片福利无码网址| 九九在线中文字幕无码| 成人大尺度做爰视频网站| 国产午夜成人免费看片无遮挡| 日本A片成人片免费视频生活片| 嫩BBB槡BBBB槡BBBB免费视频| 最近中文字幕在线的MV视频| 少妇挑战3个黑人惨叫4P国语| 精品自拍农村熟女少妇图片| 国产亚洲精品久久久999密臂| 小sao货叫腿张开我cao死你| 国产尤物电影在线观看网站免费| 欧美一卡2卡三卡4卡 乱码 | 九九热线有精品视频99| 国产精品系列在线观看| 好想被狂躁A片免费久99| 香蕉视频免费版在线高清全集| 伊人狠狠色丁香婷婷综合男同| a级av电影在线观看| 亚洲第一天堂国产福利| 中文天堂在线WWW最新版官网| 91精品中文字幕a| 欧美日韩精品亚洲一区二区| 女女女女BBBBBB毛片视频| 黑人搡BBBBB搡BBBBB| 300部大龄熟乱视频| 丰满女子BBWBBWPICS| 超碰97人人做人人爱亚洲尤物| 天天天天噜在线视频 | 99精品无人区乱码在线观看 | 色欲久久精品AV无码| 精品国产粉嫩内射白浆内射双马尾| 国产免费踩踏视频网| 2020中文在线一区二区三区| 女人与牲囗牲恔视频免费| 国产AV天堂无码一区二区三区 | 人妻一区二区久久久久久久网站| 卡一卡二卡三乱码厨房| 积积对积积的桶免费观看不下载| 国产一卡2卡3卡四卡精品| 自拍亚洲欧美变态重口| 国产mv欧美mv日产mv观看| 2222av.com| 亚洲AV无码一区二区A片成人| 最近中文字幕高清中文字幕MV| 一本道在线无格视频| 五月丁香色五月综合网| 4399少妇做受免费A片| 国产成人av一区二区三区无码| 国模少妇一区二区三区A片| 成年女人免费视频播放7777| XUNLEIGE在线观看| 亚洲va在线∨a天堂va欧美va| 国产喂奶挤奶一区二区三区| 亚洲free性XXXX护士白浆| 91福利华人在线观看| 热热色原网址20岁以下| 久久精品香蕉绿巨人登场| 好硬啊进去太深了A片| 国产开嫩苞视频在线观看| 天天日天天日天天爽天天射| 春暖花开 网友自拍区| 国产色精品久久人妻无码看片软件| 日韩在线视频www色| 成人A片产无码免费视频软件| 精品麻豆剧传媒AV国产| 国产沙发午睡对白高清| 国产AV久久久久精东AV| 国产制服精品一区二区| 亚洲一卡二卡三卡四卡无卡网站| 视频一区二区77在线| 大黑鳮巴视频欧美| 自拍偷拍av一区二区| 国产精品系列在线观看| АⅤ天堂 中文在线| 欧美一区二区三区成人A片| 2020中文在线一区二区三区| 永久免费看成人A片在线播放| 男人天堂影院WWW94| 老头下边又粗又大又硬| 日本老狼一卡2卡3卡4卡在线| 激烈娇喘叫1V1高H校园视频| J8又粗又硬又大又爽又网站 | 国产大尺度吃奶无遮无挡| 五月丁香色五月综合网| 色综合久久88色综合天天6| 欧美躁天天躁无码中文字| 免费观看的国产精品| 欧洲一卡2卡3卡4卡免费高清| 日日碰狠狠躁久久躁96AVV| 亚洲AV永久综合在线观看尤物| 92午夜福利免视频100集2019| 国产成人a在观看网站国产成人| 影音先锋成人色情影片| 日本不卡不码高清免费| 少妇又爽又大又黄蜜桃| 欧美日韩精品一区二区三区高清视频 | 爱啪网亚洲第一福利网站| 人人操人人操人人操| 欧美激情无码成人A片| 成av人片一区二区三区久久 | 中文字幕一区二区三区人妻少妇在线| 999久久欧美人妻一区二区| 人妻含泪让粗大挺进| 久久成人做爰电影图片| 国产乱人对白A片麻豆| 69免费在线视频| 亚洲综合日韩欧美一区二区| 中文字乱码电影在线播放 | 午夜精品电影高清完整版| 久久久这里只有免费精品2018 | 亚洲 自拍 色综合图区| 国产午夜精华精华精华婷 | 日韩人体做爰大胆337P| 国产AV无码片毛片一级流奶水| 精品一卡2卡三卡4卡乱码免费| 99re6国产在线播放精品| 香草视频WWW在线看| 久久av色欲av久久蜜桃麻豆| 久久久久久久久66精品片| 9420高清视频在线观看2019| 男人的天堂网2018观看| 无人区乱码1区2区3区网站| 好久被狂躁A片视频无码免费视频| 国产成人av一区二区三区无码| 亚洲va欧洲va国产va不卡| 视频在线中文字幕一区在线| 国产亚洲精品久久久久久移动网络 | 牲高潮99爽久久久久777| 国内毛片毛片毛片毛片| 苍井空《美人妻》| 女人自熨全过程直播| 丰满少妇啪啪呻吟69XX| 日韩放荡少妇无码视频播放| 色情A片成人网站免费看视频| 欧美巨大黑人精品videos| 浮妇高潮喷白浆视频 | 日本国产精品无码字幕在线观看| 免费无码婬片AAAA片软件| 中文字幕日韩视频在线| 日本高清不卡网站免费| 女人被躁到高潮嗷嗷叫游戏| 国产亚洲精品久久久无码狼牙套| 亚洲AV无码乱码在线观看性色| 苍井空《美人妻》| 国产人成无码视频在线观看 | 拍真实国产伦偷精品| 色日韩在线视频全集| 国产精品亚洲精品日韩一本大全| aaaa黄百度影音| 国产又粗又猛又爽又黄A片漫画| 国产精品一区二区三区免费 | 麻豆最新在线人成免费观看| 污到你湿的动态图片gif| janpanese20er成熟| 香焦视频在线观看黄| 色诱视频网站免费观看| 美女把尿囗扒开让男人添| 囯产少妇BBBBBB高潮喷水一| 色情www日本欧美| 97在线看午夜福利| 在线高清无码欧美久章草| 日本熟妇乱人伦A片一区| 鲁大师在线看片在线| 色情A片成人免费观看视频| 无码日本大胆XXXX| 成片一卡三卡四卡免费网站| 五月综合激情婷婷六月| 中国日本韩国免费观看视频| 亚洲精品无码成人A片色欲| 亚洲精品国产嫩草在线观看东京热 | 亚洲人大战欧洲人A片| 午夜尤物禁止18点击进入| 国产乱人乱偷精品视频a人人澡| 日韩精品亚洲专在线电影| 成人免费AA片在线观看| 国产国语特级 a毛片| 中文精品卡1卡二卡3卡四卡| 久草视频免费在线观看| 一边吃胸一边摸着下面的污污| 久久人搡人人玩人妻精品l演员表| 亚洲精品久久久WWW小说| 亚洲国产精品无码久久eeuss| 日韩一区二区在线观看视频| 国产高清精品国语特黄A片| 麻豆AV福利AV久久AV| 高清一卡二卡三卡四卡免费观在线 | 胸大美女又黄的网站| 2024伴郎粗大内捧猛烈进出| 高铁厕所8分半视频在线| 欧洲一卡2卡3卡4卡免费观看| 91精品中文字幕a| 轻点灬公大JI巴又大又小说 | 欧美成人做爰高潮片免费看借种| 凌晨三点看片www巨乳| 女人18毛片a级毛片| 亚洲亚洲国产精品| 国产亚洲精品久久久久久一区二区| 国产女同互慰高潮流水视频| 91人妻一区二区三区| 国产AV国片精品 | www.3344日本午夜福利| 人妻不敢呻吟被中出A片视频| 亚洲AV成人无码久久精品贰佰网 | 毛片黄片免费播放| 狠狠躁日日躁夜夜躁A片小说天美| 老牛无码人妻精品1国产| 最近日本MV字幕免费观看在线| 佳佳黑高跟极致踩踏调教视频| 无码内射成人免费喷射| 中文字幕无码人妻AAA片| 国产又色又爽又刺激的A片| 人妻免费久久久久久久了| 91麻豆精品国产自产| 欧美AAAAAABBBBB| 日本一大新区免费高清不卡| 成人午夜视频在线观看免费 | 日本一卡二卡三卡四卡无卡免费网站 | 边做边爱完整版免费视频播放视频 | 久久精品免费人成人A片| 欧美乱大交XXXXX潮喷l头像| 亚洲综合日韩欧美一区二区| 97se亚洲综合自在线尤物| 精品久久久久久无码人妻蜜桃免费 | 大地资源色婷婷视频在线| 人妻熟女一二三区夜夜爱| 欧美成人精品一区二区综合A片| 好爽插到我子宫了高清在线| 成片免费观看视频潢片| 日本黄A级A片国产免费| 男男做爰猛烈高潮在线观看| 国产人妖在线另类专区| 男插女一起爽的免费樱花小视频| 国产裸体精品免费观看| VA在线看国产免费| 精品久久无码人妻人伦Av| 丰满熟妇人妻中文字幕| 依人青青青在线观看| 国产无遮挡无码网站| 亚州免费A片无码区A片| 国产开嫩包视频在线观看| 国产无遮挡无码网站| 国产美女裸体无遮挡网站 | 小骚妇下面水多要插视频| 亚洲中文字幕无码va| 日韩视频一中文字暮| 99噜噜噜在线播放| 潘金莲之前世今生床戏| 久久草这里全是精品香蕉频线观| 一个人在线观看的WWW视频日本| 国产一a毛一a毛A免费看图 | 国产AV一区二区熟女人妻| 8090成年在线看片| 亚洲欧美日韩国产中文| 97精品人妻一区二区三区香蕉| 国产黄a一级二级三级看三区| 色综合久久88色综合天天6| 免费无人区男男码卡二卡| 免费区大尺码体验区| A片好大好紧好爽视频| 国产99热在线观看| 欧美精品VIDEOSEX极品| 国产天堂网一区二区三区| 亚洲综合色五月久久婷婷 | 午夜天堂AV久久久噜噜噜| 成av人片一区二区三区久久| 久久国产精品免费一区二区三区| 久久久久亚洲视频| 搡女人真爽免费视频大全| 男女国产猛烈无遮挡色情| 国产午夜男女爽爽爽爽爽| 成人午夜特黄AAAAA片男男| av老司机色爱区综合| 用舌头去添高潮无码AV在线观看| 色诱视频网站免费观看| 亚洲福利无码一区| 久久视频精品38线视频在线观看 | 国产精品日本无码久久一老A| 91天堂精品在线观看| 18禁欧美猛交XXXXX无码 | 日韩上萬網友分享国产黄色av心得 | 奶大灬舒服灬太大了一进一出| 欧美精品3atv一区二区三区| 亚洲精品国产一区二区精华液 | 色欲AV久久一区二区三区| 国产熟妇另类久久久久婷婷| 影音先锋爱色资源网| 国产成人无码精品久久久最新A片 国产婬A片999片免费网站 | 在线视频久久只有精品| 无码国产精品成人午夜视频| 天天躁恨恨躁都躁200次 | SE网站在线观看免费视频| 麻豆AV久久AV盛宴AV| 91精品久久久久久综合五月天| 一个人在线观看的WWW视频日本 | 久久久无码精品成人A片| 久久va成人高潮喷潮| 小小拗女一区二区三区| 国产+日韩+欧美高清视频| 又大又粗又爽18禁免费看| 亚洲AV成人无码久久精品A片| 国产原创AV在线| 乖女的嫩嫩小嫩水真多第1集| 老头下边又粗又大又硬| 国产特级毛片??????毛片| 超碰97人人做人人爱亚洲尤物| 放荡人妻少妇中文字幕91| 成人免费看片又大又黄| 国产剧情演绎在线视频| 在线精品亚洲欧美日韩国产| 国产婷婷色一区二区三区在线| 99国产欧美精品久久久蜜芽麻豆| 三级久久高清欧美| 国产又爽又大又黄A片美女裸体| 亚洲一区二区女搞男| 成人A片产无码免费视频软件| 国产电影无码午夜在线播放| 丁香天婷五月天综合网| 国产无遮挡A片又黄又爽女同| 依人青青青在线观看| 日小骚B少妇真舒服| 韩国精品AV一区二区三区| 搡女人真爽免费视频大全| 精品日韩一卡2卡三卡4卡乱码| 69精品国产久热在线观看| 国产AV天堂无码一区二区三区 | AV国産精品毛片一区二区在线| 91精品国产91 | 日本一卡二卡三卡四卡无卡高清视频| 亚洲av成人免费在线观看| 2019中文字幕视频| 人人妻精品视频免费| 日韩国产人妻一区二区三区| 男插女一起爽的免费樱花小视频| 国模少妇一区二区三区A片| 丁香花在线视频完整版| 免费国产在线视频你懂得| 无码内射成人免费喷射| 国产成人久久AV免费高潮| 国产在线二区三区熟女A级| 日本精品人妻无码免费大全| 一本大道香蕉大无l在线吗| 4444亚洲人成无码网在线观看| 爆乳少妇无码a在线观看| 又大又硬又粗做大爽A片| 亚洲AV无码国产精品色字幕综合| 啦啦啦影视韩国电影| 春水堂视频永久网址| 国产精品日本无码久久一老A| 日产精品一卡2卡三卡四| 久久97精品久久久久久久看片| 国产免费成人在线视频| 18禁美女黄网站色大片免费看| 日本高清2018字幕| 国产欧美丝袜另类第三区| 国内露脸少妇精品视频| 日本人妻中文字幕有码在线视频观看视频| 欧美激情一区二区三区四区| 亚洲天堂在线观看视频| 午夜福利麻豆国产精品| youjizz.com相似网| 欧美激情一区二区三区四区| 色偷偷超碰av人人做人人爽 | 99在线观看精品免费观看| 午夜A片无码福利1000集| 98久久无码一区人妻A片蜜| 国产毛多水多女人A片色情舞| 国产AV无码片毛片一级流奶水 | 97无码国产精品擁有海量影視資源 | 亚洲丰满熟妇XXXX性A片| 亚洲一卡2卡3卡4卡乱码 在线| 口内射精颜射极品合集| 久久青草国产手机看片福利盒子| 久久精品人妻无码一区二区三区盗| 精品日韩一卡2卡三卡4卡乱码| 在线观看国产对白网站视频免费| 99久久精品免费看国产一区福利| 亚洲一区欧洲一区| 亚洲精品国产一区二区精华液 | 国产AV99激情久久无码天堂| 96精品成人无码A片观看金桔| 日本艳妓BBW高潮一19| 在线精品一卡乱码免费| 亚洲精品成人区在线观看| 免费无码又爽又刺激A片涩涩在线| 嫩BBB槡BBBB槡BBBB免费视频| 国产高清精品国语特黄A片| 色婷婷欧美在线播放内射| HEYZO无码中文字幕人妻| 老色鬼久久亚洲AV综合0男男 | 99久久国产露脸精品国产吴梦梦| 欧美日韩精品一区二区三区四区| 欧美成人A片免费无码毛片| 久久久成人A片免费一区二区三区| 国产69精品久久久久久久久久久久| 精品久久久久久中文字幕o| 色情A片成人网站免费看视频| 亚洲国产精品美女久久久久AV | 亚洲AV国产成人精品区三上悠亚| 国精品午夜福利视频不卡麻豆| 国产mv欧美mv日产mv观看| 2019最新久久久视频精品| 黑人欧美巨大xxxxx69| 欧美.亚洲.日韩.天堂| 亚洲天堂在线观看视频| 97亚洲熟妇自偷自拍另类图片| 日日碰狠狠躁久久躁综合网| 2023国精产品一二二线免费 | 亚洲精品一区二区绿巨人| 成片一卡三卡四卡免费网站| 中文乱码一线二线三线| 国产免费看又黄又大又污的胸| 丝袜长腿日韩一区中文字幕| 嫩B人妻精品一区二区三区| 99爱在线精品视频网站| 欧美精品1区2区3区| 国产嫖妓一区二区三区无码 | 波多野结衣巨乳女教师6| 久久99蜜桃精品久久久久小说| 六月丁香综合在线视频| 2020最新国产精品极品| 西西人体做爰大胆| 日韩AV无码一区二区三区不卡毛片 | 国偷自产AV一区二区三区健身房 | 国产AV高清怡春院| 乱码午夜-极品国产内射| 成年女人免费影院播放| 国产一级片内射视频蘑菇视频| 无码精品黑人一区二区三区不卡| 玩弄放荡人妻一区二区三区| 国产欧美三级在线观看| 公与我做爽了A片视频| 成人激情综合网影院在线观看| 成人影院人人免费| 天堂一日韩中文字幕| 国产一级片内射视频蘑菇视频| 国产精品成人一区二区无码久久| 精国产品一区二区三区A片| 成人做爰A片免费视频日本 | 久久精品免费人成人A片| 和两个男人玩3P好爽视频| 果冻传媒色AV国产播放| 九九久久精品国产免费看小说| 日韩美女av一区二区| 亚洲A∨无码精品午夜电影| 亚洲一卡二卡三卡四卡无卡网站| 成年人网站免费观看视频| 精品久久久久久中文字幕o | 国产日韩欧美中出另类| 最近2019中文字幕大全视频10| 超碰在线成人av| 成人网站在线观看免费| 爆乳JUFD492汗だく肉感| 5566中文字幕永久| 麻豆乱码国产一区二区三区| 亚洲精品久久无码AV片银杏| 成人AV在线天堂一区二区三区| 免费国产美女爽到喷出水来视频| 成人区人妻精品一区二欧美毛片| 上课学长扒开腿揉捏花蒂| 后入内射无码人妻一区| 99re热免费精品视频观看| 成人无码免费A片免费看软件| 精品视频在线一区| 色情无码WWW视频无码区下载| 2019精品国产品免费观看 | 极品吹潮视频大喷潮tv| 成人午夜视频在线观看免费 | 成人国产三级视频在线观看| 国内精品偷拍在线观看| 91午夜精品亚洲一区二区三区| 天津老熟女高潮A片视频| 亚洲另类无码专区国内精品| 日本成人一区二区三区| 人妻边打电话边被躁91| 和老外3p爽粗大免费视频| 又硬又粗进去好爽A片欧美| 女人色国产a精品| 亚洲va欧洲va国产va不卡| 欧美激情合集HB老司机在线 | 亚洲极美女高清视频| 噜噜噜AV在线观看| 人人爽久久涩噜噜噜AV| 欧美又粗又大又爽的A片| 无码国产精品成人午夜视频 | 日本动漫爆乳H无码黄漫动| 好男人在线视频神马影视WWW| 天堂一日韩中文字幕| 亚洲国产精品日本无码网站| 亚洲精品久久久久久中女字幕| 国语两人做人爱费视频| 91精品视频在线| 97久久综合亚洲色hezyo | 亚洲精品无码av无码专区一本| 出轨人妻无套激情内射| AV免费网站在线观看| 久久se精品一区二区国产| 人禽无码做爰在线观看视频| 直接看的成人无码视频网站| 浮妇高潮喷白浆视频| 四虎影视2019最新址| 国产开嫩包视频在线观看| 欧美h版在线观看| 成人啪啪免费无码网站| 日本无码色情影片在线看| 国产真实乱人偷精品人妻69| 熟女AV之人妻熟女| 无码日日爽夜夜爽| 影音先锋影院中文无码| 白丝高中生被C到爽哭视频| 午夜福到在线4国产| 色情免费网址直接观看| 久久久久久九九97精品中文无码| 日日摸天天碰中文字幕你懂的| 最近最好看的2018中文字幕国语| 午夜天堂AV久久久噜噜噜| 噼里啪啦国语版在线观看| 国产精品顶级A片无码久久久| 色情无码永久免费网站WWW| 黑色丝袜美腿美女被躁翻了| av大片在线网站| 扒开双腿粉嫩流白浆视频| 最近最新的日本中文MV| 亚洲第一天堂国产福利| 国产妇少水多毛多高潮A片小说| 亚洲AV无码乱码精品裸果| 亚洲综合日韩欧美一区二区| 亚洲日本国产综合高清| 桃谷绘里香初尝黑人巨炮网址| 亚洲欧美一区二区成人片| 露营野外帐篷奶头舔齐根没入小说 | 久久久久久久999| 国产人妻精品一区二区三水牛影视| www.48123.com| 积积对积积的桶免费观看不下载 | 91国偷产自一区二区三区| 99国产精品久久人妻无码| 日本熟妇乱人伦A片一区| 亚洲AV无码成人啪啪| 狠狠躁日日躁夜夜躁A片小说天美| 越南美女内射BBWXZ| 91成人免费观看网站| 2019中文字幕视频| 91成人国产麻豆一区二区| 成人午夜精品网站在线观看| 国产综合亚洲日韩| 国产午夜成人免费看片无遮挡| 日本人强伦姧人妻A片| 无套内谢大学生A片| 国产香蕉视频在线观看| 国产69精品久久久久91不卡| 不带套绝色中出中文无码 | 真实国产熟女人妻AV17P| 麻豆视传媒短视频免费观看| 狼有福利在线观看亚洲欧美| 高潮好爽视频在线观看| 东京热456大交乱高清视频| 亚洲乱码在线卡一卡二卡新区| 国产熟睡乱子伦视频在线观看| 午夜做爰XXXⅩ性高湖视频美国| 亚洲极美女高清视频| 久久se精品一区二区国产 | 高清一卡二卡三卡四卡免费观在线 | 亚洲精品国产SUV| 男生女生一起愁愁愁很痛| 爽到高潮喷水不停尿失禁男| 2023国精产品一二二线免费| 最近中文字幕电影免费MV| 亚洲日本久久久午夜精品| 玩异少妇一区二区A片| 国产黄色片在线免费看| 精品人妻无码一区二区三区在线| 国产精品网站在线观看免费传媒| 免费啪视频观看视频| 一女被二男吃奶A片视频| 久久精品免费人成人A片| 安徽妇搡bbbb搡bbbb| 2222av.com| 无码一区二区三动图| 忘忧草中文字幕资源网| 69网站黄色免费观看 | 豪妇荡乳1一5杨贵妃| 2019爱久久视频| 国产亚洲精品久久久999无毒 | 欧美特级特黄AAAAA片| 波多野吉AV无码AV乱码在线| 17CC网黑料爆料一区二区三区| 三人荫蒂添的好舒服A片 | 亚洲国产成人免会观看| 爽爽精品DVD蜜桃成熟时电影院| 年轻的妺妺伦理HD中文| 日本一区二区高清片片| 夜夜春极品少妇操出白浆| 国产男女猛烈无遮挡A片小说| 欧美jizzhd精品欧美满| 小草久久人热国产| 国产精品人妻无码久久久豆腐| 国产丰满老熟妇乱XXX1区| 色偷偷男人的天堂a v| 日日噜噜噜夜夜爽爽狠狠| 中文字幕一区二区人妻免费不卡| 欧美精品1区2区3区| 国模欢欢大尺度床戏啪啪| 欧美又大又粗限制A级福利群| 欧美精品狠狠色丁香婷婷| se01在线看片| 国产精品色哟哟网站高清| 半夜摸妺妺乳C起来好疼| 亚洲男人天堂网2014av| 国产色情一区二区不卡毛片| 免费无码又爽又刺激高潮的动态图 | 又硬又粗进去好爽A片免费视频| 国产精品久久人妻拍拍水牛影视| 成年午夜免费韩国做受视频| 久久精品出轨人妻国产| 亚洲精品做爰无码片麻豆| 精品乱码一卡2卡三卡4卡网| 无码动漫h磁力资源| 漂亮的保姆5在线观看完整版| 永久无码日韩A片免费看麻豆精品| 亚洲精品久久久午夜福利电影网| 粉嫩av懂色av蜜臀av熟妇| 欧美一级淫荡免费观看| 国产乱码一二三区精品| 婷婷国产亚洲精品网站| 乐播AV永久无码精品一区二区| 91在线精品亚洲第一区香蕉| 国产免费成人在线视频| 午夜成人亚洲理伦片在线观看| 又黄又大又猛的A片| 无码成人一区二区三区入厕偷拍| 六月丁香综合在线视频| 免费99精品国产人妻自在线| 在线亚洲午夜片AV大片| 色情www日本欧美| 国产午夜成人免费看片无遮挡| 欧美精品1区2区3区| 日韩欧美视频一区二区| 欧美劲爆婷婷五月久久| 99国产精品人妻无码免费| 日本一道人妻无码一区在线| 四虎影视8848aamm在线观看| 激情综合五月亚洲婷婷| 张柏芝BBw搡BBBB搡BBw| 香蕉视频免费版在线高清全集 | 97色情在线观看免费高清| 狠狠噜天天噜日日噜久久久电影 | 免费看欧美A级黄色绿像| 小sao货叫腿张开我cao死你| 亚洲2卡3卡4卡5卡乱| 人妻少妇69式99偷拍| 丰满少妇大力进入A片中文| 亚洲 自拍 色综合图区| 国产SUV精品一区二区6 | 麻豆AV久久AV盛宴AV| 成a在线观看视频播放| 亚洲欧洲日产国码韩国| 人妻少妇精品无码一区二区三区| 91精品国产免费久| 亚洲欧美偷拍综合图区| 国产三级做爰在线播放| 麻豆乱码国产一区二区三区| 无码动漫h磁力资源| 久久国产精品免费网站| 欧美日韩不卡一区视频在现| 国产成人无码精品亚洲| 日本精品自拍日韩| 久久精品国产久精国产| 日本精品人妻无码77777| WWW.色噜噜.COM| 国产片?V片永久免费观看| 人妻少妇主动迎合嗯啊A片| WWW免费刺激无码又爽又色视频 | 99人人妻人人爽人人| 99久久综合国产精品免费| 亚洲少妇久久久久| 亚洲1区2区3区精华液| 啦啦啦影视韩国电影| 岳的大肥屁熟妇五十路99| 巨胸爆乳美女漏双奶头A片 | 免费v片所有免费网站| 国产成人精品a视频三区| 真人女性生图片高清黑毛| 亚洲AV国产成人精品区三上悠亚| 2023国精产品一二二线免费| 日产一卡2卡三卡乱码在线下载 | 波多久久亚洲精品AV无码| 99V久久综合狠狠综合久久| 国产色婷婷亚洲99精品小说| 大乳秘书被CAO到哭H| 国产乱码一卡二卡3卡4| 成人性生交A片免费直播| 啊用力嗯轻一点男同软件| 久久99蜜桃精品久久久久小说| 国产精品久久国产精品99盘| 99久久精品免费观看国产| 日韩一卡2卡3卡4卡乱码网站导航 我的初次内射欧美成人影视 | 欧美又爽又大又黄A片| AV色情抓胸吃奶免费观看| 狠狠色综合婷婷网| 丰满少妇大力进入AV亚洲| 欧美成人猛片AAAAAAA| 国产人在线成免费视频| WWW国产亚洲精品久久麻豆| 日本黄A级A片国产免费| 男女多P混交群体交乱A片小说| 91亚洲精品五月天| 2020精品国产自在现线看| 国产精品视频白浆合集| 2019一本大道香蕉大在线| 亚洲AV国产成人精品区三上悠亚 | 狼有福利在线观看亚洲欧美| 91中文字幕国产| 国产SUV精品一区二区| IJZZIJZZIJZZ教师水多| 日韩一区二区视频在线观看| 日韩美女乱淫试看屁视频网站 | 暖暖视频免费最新中文字幕 | 成人亚洲视频在线观看| 在线精品一卡乱码免费| 五月婷婷激情第四季| 精品夜夜澡人妻无码AV| 成人欧美一区二区三区A片| 久这里只精品99re66| 亚洲综合日韩欧美一区二区| 国产灬性灬淫…乱…视频…| 亚洲高清91在线| 久久国产露脸精品国产| 不卡欧美一区二区三区视频| 国产又粗又大又爽的A片精华液| 日本高清一区免费中文视频| 亚洲精品无码AV一区二区| 国产成人91一区二区三区APP| 丰满少妇啪啪呻吟69XX| 91精品国产高清在线观看| 蜜臀国产一区二区三区无码A片| 人妻体体内射精一区二区| 胸大美女又黄的网站| 又色又爽又黄的A片免费看苍井空| 亚洲free性XXXX护士白浆 | 亞洲歐美日韓精品綜合網| 日本网站网站大全A片| 久久婷婷五月综合色丁香| 欧美又粗又黄又硬的A片| 超薄肉色丝袜一二三四区| 一道本视频一二三区| 国产黄色片在线免费看| 超碰中文字幕日本| 欧美18精品久久久无码午夜福利 | 欧美成人精品动漫在线专区| 国产一卡2卡3卡四卡精品| 亚洲一卡2卡3卡4卡乱码 在线| 国产色婷婷亚洲99精品小说 | 成人国产精品免费视频观看| 99在线观看精品免费观看| 国产高潮流白浆视频| YYY111111日本无码| 专区亚洲欧洲日产国码AV| 中文字幕亚洲码 在线观看| 亚洲另类无码专区国内精品| 751.t 白羊直播| 2021最新亚洲精品无码| 神马午夜福利不卡片在线| 国产妇精品伦一这二区三| 成人无码T髙潮喷水A片动漫| 久久97久久97精品免视看| 国产高清精品国语特黄A片| 最近中文字幕高清中文字幕MV| 国产二级一片内射视频播放| 无码人妻丰满熟妇A片护士M| 丰满人妻熟女中文字幕AⅤ| www.3344日本午夜福利| 免费无码又爽又刺激A片软| 国产乱对白刺激视频| 丰满人妻妇伦又伦精品国产| 丰满少妇黑森林A片| 强壮的公么征服我 在线看| 播放真实国产乱子伦视频| 2019看片w网址| 正在播放高清无码国产 | 少妇被躁爽到高潮无码A片小说| 免费乱理伦片在线观看夜| 超薄肉色丝袜一二三四区| 越南女子杂交内射BBWBBW | 欧美Z0Z0人牲交| 99久久婷婷国产一区二区| 十八禁无码啪啪无遮挡网站| 粉嫩小又紧水又多A片| 欧美精品VIDEOSEX极品| 久久这里只有精品免费看青草| 无码日本精品一区二观看| 无码少妇秘一区二区| 日韩精品亚洲专在线电影| 最近最新的日本中文MV| 色综合久久精品亚洲国产消防| www.3344日本午夜福利| 亚洲A片又硬又粗又爽小说| 日本又黄又爽gif动态图| 日本丰满熟妇被捏出奶水 | 精品1卡二卡三卡四乱码| 老色鬼久久亚洲AV综合0男男 | 日本不卡不码高清免费| 91久久人澡人人添人人爽| 国产小伙和50岁熟女23p| 狠狠色丁香久久婷婷综合图片| 成人福利在线免费观看| 强壮公让我高潮八次苏晴| 欧美日韩成人精品久久久免费看| 日本无码色情影片在线看| 久久HEZYO久综合亚洲色| 美女好紧好大好爽12p| 少妇成熟A片无码专区小说| 女人十八毛片水真多啊| 国产成人精品视频VA片| 最近中文字幕在线的MV视频| 免费看YYYY片视频软件| 揉同学母亲巨乳巨乳先锋影音| 亚洲日韩国产成网在线观看| 91成人免费观看网站| 亚洲欧美一区二区成人片| 日韩国产成人无码AV毛片蜜柚| 内射少妇36P亚洲区| 色情毛片AAAAAA片毛片| 2019看片w网址| 中文字幕亚洲综合小综合在线 | 亚洲AV又黄又爽超级A片软件| 人人妻人人爽人人添夜夜| 久久国产亚洲精品AV麻豆| http www.you jizz| 亚洲综合久久成人AV| 日本老狼一卡2卡3卡4卡在线| 成 人 黄 色 免费 网站无毒| 2019看片w网址| 玩弄少妇高潮A片XXX| 在线播放无码后入内射少妇| 中文字幕乱码免费专区| 少妇真实被内射视频三四区| 国产成人盗摄在线视频| 日韩一卡2卡3卡4卡乱码网站导航 我的初次内射欧美成人影视 | 亚洲精品久久久久久一区| 国产69精品久久久久91不卡| 国产91专区视频在线观看| 色YEYE在线视频观看网站| 国产剧情福利AV一区二区| 青青小草国产在线播放| 露营野外帐篷奶头舔齐根没入小说 | 久久久精品理论A级A片| 日韩欧美视频一区二区| 国产精品人妻无码一区二区三区| 国产成人av一区二区三区无码| 亚洲AV秘无码一区二区三竹菊| 精品亚洲国产成AV人片传媒| 91福利华人在线观看| 亚洲AV国产成人精品区三上悠亚| 国产免费成人在线视频| 人妻无码一区二区三区欧美熟妇 | 娱网高清 hd1080| 成人国产精品久久久久久亚洲| 免费乱理伦片在线观看2020| 九九热在线这里只有精品| 粗暴蹂躏无码AV一二三区| 国产午夜精华精华精华婷| 国产色情A久久无码影| 国产精品久久久久久亚洲色欲| 一本大道视频大全在线| 免费日韩中文字幕高清电影| 999久久久国产综合精品| 五月婷婷激情第四季| 亚洲无人区码一码二码三码的特点| 萌白酱17分钟视频| 99久久精品国产一区二区三区 | 久就热视频精品免费99| 国产永精品亚洲精品| 国产极品JK白丝玉足喷白浆| 真人性23式(动)| 萝莉社动漫在线观看| 欧美中文字幕一区二区三区老色批 | 99精品又大又爽又粗少妇毛片| 影音先锋爱色资源网| av三级国产a级水| 日本艳妓BBW高潮一19| 夜来香AV在线观看| 国产嫖妓一区二区三区无码| 终极蜘蛛侠动画片全集| 亚洲春色中文字幕久久久-三上亚| 亚洲国产精品色情777777| 国产乱对白刺激视频| 亚洲免费人成在线观看网站| 精品人人搡人妻人人玩A片| 成人A片产无码免费视频软件 | 国产av剧情一区二区三区| 欧美人与动牲交ZOOZ乌克兰 | 欧美成人猛片AAAAAAA| 视频一区二区日韩在线播放| 麻豆国产精品AV色拍综合| 99视频免费在线| 国产一级片内射视频蘑菇视频 | 青青草AV国产精品| 国产AV高清怡春院| 少妇性BBB搡BBB爽爽爽毛片| 欧美叉叉叉BBB网站| 亚洲AV久久无码精品九九九小说| 麻豆色情少妇传媒AV一| 《丰满的女邻居》在线观看| 国产91视频观看| 成a在线观看视频播放| 天津老熟女高潮A片视频| 97人妻中文字幕碰碰视频| 嫩草AV久久伊人妇女| 2018国产精华国产精品| 无码AV综合AV亚洲AV| 人妻野战三级做爰| 性一交一免一费一视一频| 丰满少妇69激懒啪啪无| 成人国产在线观看| 2021国产成人精品不卡| 免费麻豆国产黄网站在线观看| 色婷婷色综合缴情网站| 美女内射毛片在线看免费人动物| 91美女精品视频 国产| 成人免费视频软件网站| 七月丁香五月婷婷首页| 亚洲欧美日韩国产中文| 国产做爰一区二区三区四区| 亚洲精品久久久久一区二区三区| 摸BBB揉BBB揉BBB视频| bt种子下载 成人无码| 自拍亚洲欧美变态重口| 国产91视频观看| 国产亚洲一区二区三区啪| 欧美一区二区三区成人A片| 国产AV国产精品白丝JK制服| 国产开嫩苞视频在线观看 | 国产精品毛片AV在线看| 边摸边吃奶做爽A片视频| 国偷自产AV一区二区三区健身房| 啊轻点灬大JI巴太粗太男男| 999久久狠狠免费精品| 亚洲国产精品素人在线观看| 日韩精品色情AV无码一区| 东北小伙子CHINESE直播飞机| 粉嫩AV国产一区二区三区| 国产精彩视频精品视频精品| AV色情抓胸吃奶免费观看| 2022一本久道久久综合狂躁| 大香焦在线伊人74| 国产又黄又爽又猛免费视频播放| 国产在视频视频2019| 萌白酱17分钟视频| 摸添揉捏胸还添下面视频| 丰满人妻熟妇乱偷人无码| 国产不卡成人手机在线| 2019天堂在线手机| 日韩精品色情AV无码一区| 亞洲歐美日韓精品綜合網| 色欲久久精品AV无码| 在线 国产 有码 亚洲 欧美| 自拍偷拍午夜福利| 亚洲综合丁香婷婷六月香| 老头舔女荫道口视频| av电影亚洲精品区| 免费全部黄A片免费播放| 亚洲精品乱码久久久久蜜桃| 国产91无码一区二区三区噜| 人人人爽人人澡人人高潮| 色欲AV蜜臀AV在线观看麻豆| 中文字幕不卡一区| 美女视频黄的全是免费| 丰满美女中文字幕一二三四五六七 | 欧美做受高潮69日本动漫| 在线欧美精品一区二区三区| 四川少妇bbw搡bbbb槡bbbb| 私人俱乐部在线视频| www.夜夜撸.com| 男人天堂网2020| 亚洲精品爆乳一区二区H| 中文幕无线码中文字夫妻| 午夜性啪啪A片免费AAA毛片| 偷拍与自偷拍亚洲精品| 搡女人真爽免费视频网站| 国产无遮挡A片无码免费软件| 97精品视频在线观看0| 97人妻东京热无码一区二区 | 成人性做爰AAA片免费看不忠| 摸bbb搡bbbb搡bbb| 美女胸18以下禁止看禁网站| 国产三级片视频在线观看| 亚洲AV成人无码久久精品贰佰网| 2014av天堂网影音先锋| 国产五月色婷婷六月丁香视频| 亚洲欧洲中文日韩久久AV乱码| 一区二区三区无码高清视频| 一级毛片免费视频成人欢看| 嗯啊开小嫩苞HHH...嗯啊| 亚洲精品一区二区绿巨人| 午夜福利1000集80 视频| 亚洲尤码不卡AV麻豆| 99久久精品国产一区二区三区| 囯产少妇BBBBBB高潮喷水一| 99在线视频观看| 人妻少妇精品无码一区二区三区| 亚洲夜夜夜无代码| 欧美大屁股熟妇BBBXXX| 一本中文字字幕乱码视频亚洲欧美另类图片| 91精品久久久久久综合五月天 | 四色成人A片视频在线看| 强伦少妇A片视频| 欧美黑人性受XXXX精品| 久99国产免费动漫| 精品久久综合1区2区3区激情| 蜜桃911精品一区二区三区作者| 久久97久久97精品免视看| 99久久99热这里只有精品| 中文字幕亚洲欧美日韩2019| 6699嫩草久久久精品影院| 国产男人午夜视频在线观看 | 欧美黑人性受XXXX精品| 国产精品污www在线观看| 黑人强伦姧人妻日韩那庞大的| 亚洲午夜无码毛片AV久久| 欧美高清videossexohd潮喷| 秘密列车动漫在线观看| 丰满少妇大力进入AV亚洲| 亚洲最大天码AV在线观看| 日本高清一区免费中文视频| 成人无码区免费A片视频日本 | 性一乱一交一A片.看A片| 日日碰狠狠躁久久躁96| 国产精品熟女高潮无套| 黑人搡BBBBB搡BBBBB| 最近最新中文字幕大全手机| 四虎影视2019最新址| 国产人妻精品久久久久野外| 佳佳黑高跟极致踩踏调教视频| 欧美乱大交XXXXX潮喷l头像| 午夜精品一区二区三区在线成人| 欧美亚洲日本韩国免费网站| 91精品久久久久久综合五月天| 安徽妇搡BBBB搡BBBB| 日本xxxxxxx69xx| 7777色鬼XXXX欧美色妇 | 又大又粗又爽18禁免费看| 亚洲日本欧美日韩中文字幕 | 日韩好片一区二区在线看| 亚洲AV无码乱码国产麻豆穿越| 国产亚洲精品久久久久久禁果TV| 最近最新中文在线观看| 中日韩一卡二卡三卡四卡免| 国产成人盗摄在线视频| 日韩二丶三区视频免费| 国产乱人伦无无码视频| 麻豆第一区MV免费观看网站| 最近中文字幕MV在线2018| 无套内谢少妇毛片A片免| 好爽插到我子宫了高清在线| 一区二区三区无码高清视频| 欧美大尺BBXX黄A片| 亚洲1区2区3区精华液| 日本一二三区免费更新| 岛国小视频在线观看| 精品亚洲国产成人A片在线播放| 在线观看国产高清视频免费网站| A片扒开双腿猛进入免费观| 亚洲 日本 欧洲 欧美 视频| 最新国产精品自产在线观看 | 91亚洲高清视频在线| 91麻豆精品国产自产| 浪潮色诱AV久久久久久久| 黑色丝袜美腿美女被躁翻了| 中文字幕亚洲无线码| 亚州免费A片无码区A片| 又黄又粗暴的gif动态图| 欧一美一性一交一免一费一H一D| IJZZIJZZIJZZ教师水多| 国产高清色情在线观看APP| 人与人和人与物XXX| 乐播AV永久无码精品一区二区| 久久成人做爰电影图片| 最近中文字幕2019中文字幕8| 精品一卡二卡三卡四| 女人18毛毛片兔费码A片| 亚洲AV成人影视综合网| 亚洲1区2区3区精华液| 色妞精品AV一区二区三区| 一区二区视频传媒有限公司| 色情免费100部A片看片| 欧美精品在线电影| 91视频APP色版| 午夜做爰XXXⅩ性高湖视频美国| 九九热在线这里只有精品| 精品自拍农村熟女少妇图片 | 麻花豆传媒剧国产MV入口| 波多野结衣紧身裙女教师| 成人国产精品秘欧美高清| 91精品久久久久久久久中文字| 欧美男男gv免费网站观看| 成片一卡三卡四卡免费网站| 国产人妻777人伦精品HD| 欧美精品无码一区二区三区下载| 少妇A级裸片AAAAA八戒| 99国内偷揿国产精品人妻 | 国产无遮挡A片又黄又爽女同| 海角社区最新 在线 观看 | 亚洲美女综合香蕉片| 国产开嫩包视频在线观看| 少妇搡BBBB搡BBB搡AA| 亚洲极美女高清视频| 高清国产不卡视频| 国产女同互慰高潮流水视频| 国内乱码一线二线三线| 黑人欧美巨大xxxxx69| 精品一区二区三区免费毛片| 精品国产自在97香蕉| IJZZIJZZIJZZ教师水多| 成人无码区免费A片视频日本| 国产精品无码一区二区桃花视频 | 无限看片的视频在线看| 国产黄网页视频在线播放| 国产无套内谢普通话对白91| 91精品中文字幕一区二区三区 | 丁香天婷五月天综合网| 美女把尿囗扒开让男人添| 天美传媒AV成人片免费看| 插的痛的视频一卡二卡三卡| 久久久无码人妻精品无码| 99视频免费在线| 日本xxxxxxx69xx| 男女性杂交内射妇女BBWXZ| 最放荡的熟女人图片| 99热夜色精品三级免费观看| 免费又黄又爽又色的绿巨人| AV8888AV色情观看在线| 99精品一区二区三区| 亚洲日韩乱码中文无码蜜桃臀网站| 乖女的嫩嫩小嫩水真多第1集| 美女露全乳视频短片| 18国产成人在线| 久久精品视频在线看4| 久久草这里全是精品香蕉频线观| 色情A片成人免费看视频| 2018一本到国产手机在线| 中文字幕在线无线码中文字幕| 欧美 日韩 国产 另类 图片区 | 轻点灬公大JI巴又大又小说| 亚洲精品无码成人A片在线漫画| 在线观看肉片H漫网站| 高潮真紧好爽我视频| 午夜肉体高潮免费毛片| 91精品国产午夜福利蜜臀| 亚洲精品无码成人A片蜜臀| 国产精品反差婊在线观看| 欧美性猛交xxx大交| 成人亚洲A片V一区二区三区日本| 亚洲综合久久成人AV| 国产免费看又黄又大又污的胸 | 久久tv中文字幕首页| 6699嫩草久久久精品影院| 成人午夜激情视频免费观看| 久久草视频这里只精品99| 在线观看国产对白网站视频免费| 四虎在线观看一区二区三区| АⅤ天堂 中文在线| 精品久久久久香蕉网| 韩国乱码卡一卡二卡新区网站| 捏胸亲嘴床震娇喘视频在线播放| 亚洲乱码卡一卡二卡新区豆| 超碰97人人做人人爱少妇| 边做边爱免费看视频| 日本无码色情影片在线看| 成人动漫h一区二区在线观看| 欧美成人无码A区在线观看免费 | 超caopor在线公开视频| EEUSS鲁丝片直达入口音响| 99久久亚洲综合精品成人网| 亚洲AV无码A片一二三区| 99九九99九九九视频精品| 天堂无码人妻精品AV一区| 国产乱人伦无无码视频| www.metcn.com| 窝窝午夜理论片影院| 噜噜色wwwcom| 在线精品一卡乱码免费| WWW国产成人免费观看视频| 国产无遮挡A片又黄又爽女同| 后入白嫩网红内射99XYZ| 99精品国产亚洲| 国产精品久久久久久喷浆| 67194成l人在线观看线路1| 成人午夜福利电影天堂| 卡一卡二卡三永久榴莲视频| 男插女一起爽的免费樱花小视频| 色情无码鲁鲁A的电影| 午夜肉体高潮免费毛片| 亚洲欧美乱日韩乱国产| 国产精品亚洲综合一区二区三区| 999精品国产人妻无码系列| 国产乱人伦无无码视频| 播放真实国产乱子伦视频| 着衣爆乳揉みま痴汉电车中文字幕 | 国产熟妇搡BBBB搡BBBB搡| 少妇被又大又粗又爽毛片欧美一| 久久国产露脸精品国产| 日韩精品无码久久一区二区三| 国产寡妇乱婬一区二区三区| 鲁大师在线看日本电影| 欧美人与动牲交ZOOZ乌克兰| 中国日本韩国免费观看视频| 午夜天堂AV久久久噜噜噜| 日本九九热在线观看官网| 影音先锋亚洲AV少妇熟女| 国产精品久久久久久人妻精品流| 久碰久摸久看视频在线观看| 边吃奶边狠狠躁日韩A片| 精品人妻伦九区久久AAA片69| 强奷乱码欧妇女中文字幕熟女| 男人天堂2018在线观看97| 青青国产高清视频播放| 人禽无码做爰在线观看| 国产成人av一区二区三区无码| 粉嫩久久AV色欲AV久久| 无限在线观看播放视频直播| 不卡av一区二区在线观看| 麻豆画精品传媒2021一二三区| 国产成人va在线播放免费| 国产不卡一区二区免费视频| 少妇被又大又粗下爽A片| 麻豆天美国产一区在线播放| 国产亚洲成AV人片在线观黄桃| 国产剧情福利AV一区二区| 波多野结衣一区二区| 亚洲精品久久无码AV片麻豆 | jk制服白丝袜看内内18禁| 成av人片一区二区三区久久| 国产日韩精品v欧美一区二区三区 久久国产亚洲精品AV麻豆 | 人妻熟女久久久久久久| 国产SUV精品一区二区6| 亚洲 小说 欧美 中文 在线| 日本无码一成人免费视频| 91精品国产麻豆福利在线| 91精品视频在线| 国产成人综合亚洲A片激情文学| 四虎精品寂寞少妇在线观看| 波多野吉AV无码AV乱码在线| 热热色原网址20岁以下| 国产精品亚洲综合一区二区三区| 亚洲va欧洲va国产va不卡| 最近日本MV字幕免费观看在线| 国产精品iGAO视频网网址| 人妻野战三级做爰| 成人免费A片XxX视频流奶| 国产男人女人口高清在线播放| 国产又粗又猛又黄又爽A片| 玩弄丰满少妇高潮A片推油小说| 人妻无码一区二区三区欧美熟妇 | 国产免费踩踏视频网| 蜜臀国产一区二区三区无码A片| 国产亚洲精品久久久999密臂| 91精品无人区无豆乱码无人| 亚洲av免费在线观看| e本大道1卡2卡三不卡| 富婆大保健嗷嗷叫普通话对白 | 少妇搡BBBB搡BBB搡忠贞| 色婷婷欧美在线播放内射| 色婷婷色综合缴情网站| 欧美又大又粗又爽无码视频| 中文字幕美人妻亅U乚一596| 青青国产线观观看视频| 偷拍与自偷拍亚洲精品| 亚洲色大成网站WWW永久在线观看| 在线观看中文字幕不卡二区| 成人做爰A片免费看网站漫画| 午夜中国女人性在线| 美女裸身无档视频免费| 美女视频黄的全是免费| 国产成人精品久久一区三级| 亚洲va欧洲va国产va不卡| 色情A片成人网站免费看视频| 久久成人做爰电影图片| 一区二区三区国产| 亚洲AV无码乱码国产麻豆穿越| 无人区中文字幕免费视频| 17CC网黑料爆料一区二区三区| 亚洲男人片片在线观看 | 嫩草AV久久伊人妇女| 国产剧情演绎在线视频| 免费观看的国产精品| 国产乱码一卡二卡3卡4| 国产丰满老熟妇乱XXX1区| 国产剧情麻豆刘玥视频| 岛国在线无码免费观| 色噜噜AV亚洲色一区二区| 麻豆精产国品一二三产品区| 人人人爽人人澡人人高潮| 亚洲AV久久无码精品九号软件| 五月综合激情婷婷六月色窝| 成人精品午夜久久| 午夜亚洲WWW湿好大| 成熟妇女免费看A片视频| 91久久人澡人人添人人爽| 亚洲精品无码成人A片在线虐C| 妺妺窝人体色WWW在线播放婚闹| av中文字幕观看| а∨天堂在线中文免费不卡| 中文字幕日韩人妻| 久久99国产精品综合毛片| 国产喂奶挤奶一区二区三区| 久久久久亚洲视频| 亚州精品久久久久久久久| 亚洲AV永久综合在线观看尤物| 成人久久18秘免费网站| EEUSS鲁丝片直达入口音响| 日本公妇里乱片A片在线播放保姆| 日本一卡二卡三卡四卡免IOS| 91日韩中文字幕在线观看| 国产一a毛一a毛A免费看图| 在线观看黄A片免费AV软件| 99操在线观看国产视频| 4438成人-全国| 超碰97人人做人人爱亚洲尤物| 人与人和人与物XXX| 高清无码中文字幕影片| 免费又硬又爽又黄又免费| 日本一道人妻无码一区在线| 精品夜夜爽欧美毛片视频| 国产亚洲精品久久久久久禁果TV| av大片在线网站| 无码AV综合AV亚洲AV| 1024欧美日韩熟妇人妻| 粉嫩小又紧水又多A片| 欧美人妻WWW无码国产黄漫| 丰满少妇大力进入A片中文| 成人片毛片A片免费观看欧美| 精品久久久久香蕉网| 国产高清天干天天天| 人妻被粗大猛进猛出69国产| 欧美自拍嘿咻内射在线观看| 亚洲AV乱码一区二区三区老胖妞| 终极蜘蛛侠动画片全集| 国产成人精品亚洲精品一区色欲 | 摸BBB揉BBB揉BBB视频| 欧美 日韩 国产 另类 图片区| 性一交一免一费一视一频| 久久中文字幕人妻AV熟女| 亚洲一线黄色片在线| 国产色噜噜在线观看| 精品无码一区二区的天堂| 亚洲精品久久久WWW小说| 亚洲成A人片在线播放器| 国产又爽又刺激的视频| 玩50岁四川熟女A片| 国产毛片不卡视频在线| 91日韩精品在线观看| 久热在线这里只有精品7| 国产麻豆一级在线观看| 国产精选莉莉私人影院| 久久精品亚洲精品一区| 污视频欧美一区二区| 疯狂揉吮少妇嫩草99AV小说 | 粉嫩国产15xxxxx| 欧美熟女人妻一区二区三区| 久久人人超碰精品caoporen| 天天躁恨恨躁都躁200次 | 国产精品久久久久久熟妇吹潮软件| 安徽妇搡BBBB搡BBBB| 蜜桃人妻一区二区三区欧美| 九九久久精品国产免费看小说| 狠狠色综合婷婷网| 精品卡1卡二卡三卡乱码| 国产欧美日韩精品一二三区| 粉嫩av懂色av蜜臀av熟妇| 又大又粗又爽免费视频A片 | 亚洲精品一本之道高清乱码| 乳荡麻麻肉欲500合集| 久久久无码精品一区二区三区| 色情无码WWW视频无码区下载| 花蝴蝶免费高清视频中国| av三级国产a级水| 无码人妻久久一区二区三区蜜桃| 日本不卡免费视频新二区| 欧美黑人一级爽快片婬片高清| 久久精品免费人成人A片| 开心婷婷五月色蜜桃在线| 久久久久久久999| 和老外3p爽粗大免费视频| 激情综合五月开心婷婷| 99re热免费精品视频观看| 久久精品视频在线看4| 羞羞视频网站在线观看18岁无遮挡 | 久99久热只有精品国产99| 欧美阿v高清资源在线| 羞羞视频网站在线观看18岁无遮挡 | 国产精品高潮AV久久无码| 餐桌下的乱高H啊学长| 国产AV亚洲精品久久久久久小说| 国产亚洲精品久久久性色情软件| 国产av福利久久精品涩爱| 粉嫩国产15xxxxx| 国产成人av片免费在线观看| 免费观看高清黄页网址大全| 欧美成人午夜在线全部免费| 亚洲精品国产成人无码区A片| 把腿张开被添得死去活来在线| 特级毛片全部免费播放免下载| 99国产欧美精品久久久蜜芽麻豆| 成片免费观看视频大全| 欧美又粗又长又大AAAA片| 亚洲高清国产拍精品动图| 久久亚洲精品AV成人无码 | 色欲国产麻豆一精品一AV一免费| 国产成人午夜精品5599| 国产产一区二区三区久久毛片国语| 人妻被粗大猛进猛出69国产| 99视频这里只有精品国产| 夫目前犯人妻av中文字幕| 东北55熟妇与小伙啪啪| 精品欧美无人区乱码毛片| SE网站在线观看免费视频| 日日摸天天碰中文字幕你懂的| 欧美日韩2卡3卡4卡5卡| 天堂va欧美va亚洲va国产| 成人无码区免费A片在线软件 | 亚洲AV无码乱码在线观看性色| 精品综合日本国产| 亚洲AV无码乱码精品裸果| 国产精品人妻黑人借宿电影| 青青草a免费线观a| 最近中文字幕MV手机免费高清| 亚洲一区二区三区四区五区6区| 一本不卡视频在线久| 欧美特级特黄AAAAA片| 少妇被又大又粗又爽毛片欧美一| HEZYO加勒比久久爱综合| 色情无码WWW视频无码区下载 | 欧洲老妇60一70| 国产成熟妇人高潮A片| 久久国产露脸精品国产| 亚洲天堂免费在线| 国产亚洲精品久久久久久鸭绿欲| 国产真人性做爰视频免费40分钟| 欧美伦理精品一区二区| 小明日韩在线看看永久区域| 日本一卡二卡三卡四卡无卡免费网站| A级无遮挡超级高清-在线观看| 四十如虎的丰满熟妇啪啪| 西西人体做爰大胆图片| 亚州国产AV一区二区三区伊在| av免费在线观看最新网址| 国内毛片毛片毛片毛片| 特黄AAAAAAA片免费观看| 大陆色情免费视频观看| 亚洲精品国产精品国自产小说| 直接看的成人无码视频网站| 东京av男人的天堂| IJZZIJZZIJZZ教师水多| 嫩B人妻精品一区二区三区| 久亚洲AV无码专区A片| 亚洲av成人免费在线观看| 成人影院人人免费| 免费麻豆国产黄网站在线观看| 免费又粗又硬进去好爽A片视频| 国产精品系列在线观看| 2020日本不卡一区二区视频| 蜜月a 免费一区二区三区| 2018一本到国产手机在线| 四虎在线观看一区二区三区 | 7777色鬼XXXX欧美色妇 | 亚婷婷洲AV久久蜜臀无码| 国产内射在线激情一区| 夜夜噜2017最新视频| 黄页网址大全免费观看美女| 韩国av在线免费观看| 任你搞视频这里只有精品| 一夲道无码专区av无码A片| 国产又粗又猛又爽又黄A片漫画| 四川少妇WBBBB搡BBBB嗓| 日产一卡2卡三卡乱码在线下载 | 大陆女人内谢69XXXORG| 在线观看黄页网站大全电影天堂| 天天躁日日躁狠狠躁AV麻豆 | 金发欧美一区在线观看| 国产精品久久久久久熟妇吹潮软件| 影音先锋影院中文无码| 97国产永久网址在线观看| 又大又硬又粗做大爽A片| 最新影片日本巨波霸乳影院| 最近好中文字幕国语免费高清| 欧美又大又粗又硬又色A片| 免费99精品国产人妻自在线| 欧美精品无码一区二区三区下载| 久久AV亚洲精品一区无码 | 欧美成人午夜在线全部免费| 一级黄片免费播放| 女人高潮喷潮免费毛片| 成人av在线播放观看| 免费人成视频X8X8入口观看大| 国产亚洲AV综合一区二区A片| 2020最新国自产拍视频网站| 亚洲一线二线三线品牌精华液久久久 | 国产成人999在线| 欧美躁天天躁无码中文字| 精品久久久久久国产| 4444亚洲人成无码网在线观看| 成人啪啪爽到潮喷喷水水| 久久久久高清视频中文字幕| 国产真人性做爰视频免费40分钟| 精品日韩中文字幕无码专区| 日韩精品在线观看国产一级二级在线| 国产精品久久久久久人妻精品流| 美女裸身无档视频免费| 国产成人午夜精品5599| 亚洲欧洲日产国码中学| 鲁大师在线看日本电影| 一夜七次郎免费线路www2 | 少妇av色欲无码人妻精品| 亚洲成年人网站XXXX09| 久久久国产精品免费A片蜜芽广| 女人与公人强伦姧| 亚洲国产精品色情777777| J8又粗又硬又大又爽又网站| 欧美精品在线电影 | 成 人 网 站不卡在线观看| 最近高清中文在线国语视频| 麻豆国产人妻欲求不满谁演的| 成人啪啪免费无码网站| 久久久久高清视频中文字幕| 伊人狠狠色丁香婷婷综合男同| 欧美一级淫荡免费观看| 中文字幕无码日本欧美大片| 丰满少妇大力进入AV亚洲| 亚洲精品成人无码A片在线| 日本黄A级A片国产免费| 日本熟妇浓密毛毛多A片| 黑人强伦姧人妻日韩那庞大的| 亚洲AV无码乱码在线观看性色 | 午夜中国女人性在线| 中文字幕高清免费日韩视频在线| japanesevideo喷潮| 久久久久无码精品国产sm果冻| 性猛交╳XXX乱大交| 男人天堂影院WWW94| 日本久久久WWW成人免费毛片丨| 乐播AV永久无码精品一区二区| 性做爰A片免费视频A片直播 | 久久人人超碰精品caoporen| 最新女人另类ZOOZ0| 国产精品一区二区免费| 日韩MV欧美MV中文无码| 无码精品一区二区在线A片软件| 黄页网站18以下勿看免费| 四虎影视2019最新址| 无码天堂亚洲国产AV久久| 久久免费视频精品在线| 一女被两男吃奶添下A片V| 少妇被又大又粗又爽毛片久久黑人| 久久久国产精品免费A片蜜芽广| 在线青青视频免费观看| 1区2区3区4区产品乱码99| 免费日韩中文字幕高清电影 | 美女内射无套日韩免费播放| 国产又粗又猛又爽又黄A片 | 日韩精品色情AV无码一区| 亚洲精品少妇久久久久久海角社区| 亚洲夜夜夜无代码| 精品人妻伦九区久久AAA片69| 成AV人片一区二区三区久久| 餐桌下的乱高H啊学长| 成年美女黄网站色大片免费看 | 男人都懂的www网站免费观看 | 黑人狂躁日本妞无码A片| 最新日韩三级视频| 2021国内免费无码自拍视频网| 中文字幕久久精品无码| 国产国拍精品AV在线观看| 欧美精品无码一区二区三区下载| 不卡毛无套内射久久不| 人妻互换HD无码中文在线| 嗯嗯鲁我们不生产av我们只是 | 91在线免费视频为 | 国产妇精品伦一这二区三| 99日本人妻视频| 人妻满熟妇AV无码区国产| 麻豆精品一卡2卡三卡4卡免费观看| 久碰久摸久看视频在线观看| 久久夜色噜噜噜亚洲AV0000| 成人在线91日韩手机视频| 国产精品V无码A片在线看小说| 免费一级无码婬片A片AAA| 黄色视频AAA级毛片| 中日韩AV亚洲高潮无码| 好想被狂躁A片免费久99| 成人在线视频观看欧美日韩| 插的痛的视频一卡二卡三卡| AV无码国产精品午夜A片| 国产成人va在线播放免费| 少妇WWWB搡BBB搡BBB| 免费无码又黄又爽又刺激| 热热色原网址20岁以下| 粉嫩国产精品呻吟高潮av| 人妻丰满熟妇av无码区乱| 鲁大师在线看片在线播放| 2018国产精华国产精品| 手机午夜电影神马久久| 五月婷婷之综合缴情| 午夜福利影院私人爽| 亚洲精品成人无码A片在线| 69免费在线视频| 亚洲丰满熟妇XXXX性A片| 久久久久亚洲视频| 疯狂揉吮少妇嫩草99AV小说 | 按摩性高湖婬AAA片A片中国| 亚洲成ā∨人片在线观看无码| av电影亚洲精品区| 日日碰狠狠躁久久躁综合网| 欧美精品VIDEOSEX极品| 狼有福利在线观看亚洲欧美| 2016蝌蚪窝在线观看视频| 摸bbb搡bbbb搡bbb| 91精品福利视频| 欧美性爽交A片大全| 少妇伦子伦精品无吗| 2014av天堂网影音先锋| 精品无人区一区二区三区蜜桃小说| 国产a级黄色毛片| 久久99AV无色码人妻蜜柚| 亚洲乱码日产精品BD| 嗯灬啊灬把腿张开灬A片动漫 | 五月丁香啪啪激情综合5109| 五月婷婷激情第四季| 国产精品美女自在线观看免费| 欧洲一卡2卡3卡4卡免费高清| 国产精品久久人妻拍拍水牛影视| 国产成人无码精品久久久影院| 少妇大荫蒂被巨大爽爽| 亚洲精品久久片久久久久| 亚洲AV秘无码一区二区三竹菊| 99久久国产免费中文无字幕| 免费乱理伦片在线观看夜| 国产无线乱码新区| 给我免费播放黄色| 免费人成视频X8X8入口观看大| 免费麻豆国产黄网站在线观看| 最近中文字幕在线资源3| 一本大道一卡二卡三卡 视| 国产一区二区无码精品小说| 久久视频在线视频观看99| 日韩一卡2卡3卡4卡乱码免费| 天堂无码人妻精品AV一区| 99久久精品免费看国产一区福利| 无码精品人妻一区二区三区寡妇| 最近中文字幕免费国语6| 青青草国产97免费观看| 国产精品免费aⅴ片在线观看| 99国产精品污污污网站免费看| 91午夜精品亚洲一区二区三区| 最近最新中文字幕大全手机| 亚洲欧视在线观看| 风韵丰满熟妇啪啪熟女| 少妇少妇做爰片AA| http www.you jizz| 久久久久老熟女久久百度淫荡视频 | 精品日韩一卡2卡三卡4卡乱码| 少妇大叫太大太深受不了| 啊轻点灬大JI巴太粗A片| 欧美日韩不卡视频一区二区三区四| 依人青青青在线观看| 蜜色欲多人AV久久无码| 在线高清无码欧美久章草| 蜜臀AV99无码精品国产专区| 成av人片一区二区三区久久| 在线 国产 有码 亚洲 欧美| 被各种刑具调教吹潮高H| 91久久人人添人人爽添人 | 中文字幕日韩视频在线| 亚洲在线国产日韩欧美| 成人性三级欧美在线观看| 高清乱码一卡二卡插曲A| 好硬啊进去太深了A片| 成人无码www免费视频网站软件 | 不小心进了岳坶的身体| AV国産精品毛片一区二区网站| 国产强被迫伦姧在线观| 人妻中文字幕av无码专区| 国产特级毛片??????毛片| heyzo大桥未久持续中出| 一夲道无码专区av无码A片| 国产精品久久久久久熟妇吹潮软件| 曰本一本道a东京热播| 再深点灬舒服灬大了添JUWU| 91国产自产精品a| 无套内谢少妇毛片A片免| 国产午夜精华精华精华婷| 巨胸爆乳美女漏双奶头A片| 国产高清精品国语特黄A片| 蜜芽国内精品视频在线观看| 欧美又大又粗AAA片免费看| 午夜精品一区二区三区在线成人 | 牲高潮99爽久久久久777| 日韩精品一卡2卡3卡4卡乱码 | 国模国产精品嫩模大尺度| 欧美大尺度无遮挡A片杏仁| FREECHINESE东北女人真爽 | 北京少妇和黑人久精品| 丰满岳乱妇一区二区三区| 91成人免费网站 | 四川少妇搡BBB搡BBB搡多人伦 | 又大又硬又粗做大爽A片无册| 四色成人A片视频在线看| 免费无码AV色情在线| 成人福利在线免费观看| 国产精品99久久久久久久女警| 免费一本道性无码在线| 浪潮色诱AV久久久久久久| 精品亚洲国产成人AV在线小说| 女人喷射视频在线播放你了| 国产成人A片免费观看| 人妻夜夜爽天天爽三区麻豆AV网站| 久久国产亚洲精品AV麻豆| 人妻无码一区二区三区欧美熟妇 | 免费无码高潮又爽又刺激久久aⅤ| 欧美日韩精品一区二区三区高清视频 | 97人妻东京热无码一区二区 | 皇色在线国内外视频| 99视频这里只有精品国产| 香蕉AV亚洲精品一区二区| 成人午夜激情视频免费观看| 一色桃子中文字幕人妻熟女作品| 在线视频久久只有精品| 高清乱码一卡二卡插曲A| 久久av色欲av久久蜜桃麻豆| 精品久久久久久无码人妻蜜桃免费| 亚洲精品乱码久久久久蜜桃| 日本熟人妻人伦A片| 强伦轩人妻一区二区电影| 插的痛的视频一卡二卡三卡| 丁香蜜桃综合cb| 中文无码欧美人妻日韩精品| WWW国产亚洲精品久久| 欧美午夜艳片欧美精品| 日本高清不卡网站免费| 久久66热人妻偷产国产| www.gaoav.com| 女人色国产a精品| 成片一卡三卡四卡免费网站| 东京热456大交乱高清视频| 欧美日韩精品一区二区三区激情在线| 国产精品_卡2卡三卡4卡| 亚洲AV无码久久流水呻蜜桃久色| 久久精品国产久精国产| 国产高清无码免费a视频| 影888午夜理论不卡| 国产av福利久久精品涩爱| 成人在线观看国产一区| 91无码人妻精品1国产一区二区| 亚洲AV综合色区无码三区30p| 最近更新中文字幕2019国语1| 无码AV免费精品一区二区三区| 91精品国产闺蜜国产| 国产在线观看91香蕉| 亚洲天堂av一本道无码| 色噜噜狠狠色综无码久久合欧美 | 国产高中生三级视频| 日韩放荡少妇无码视频播放| 天美传媒色情原创精品| 日韩欧美国产精品亚洲| 色情免费网址直接观看| 国产亚洲精品久久久久久一区二区| 午夜性啪啪A片免费AAA毛片| 国内精品一区二区三区视频| 亚洲AV成人无码久久精品A片| 国产精品久久久久一区二区三区共| 精品一区二卡三卡四卡分类| 少妇A级裸片AAAAA八戒| 成人亚洲精品久久久久| 国产永久精品大片wwwApp| 色偷偷男人的天堂a v| 国产人成视频在线观看| 国产成人精品a视频三区| 无限资源w国产大片| 成人做爰A片免费视频日本| 日产区一线二线三AV| 内射精品无码中文字幕| 影888午夜理论不卡| 亚洲精品无AMM毛片| 亚洲free性XXXX护士白浆| 国产成人精品视频VA片| 欧美精品在线电影 | 欧美又黄又粗A片| 国产剧情福利AV一区二区| 国产黄色片在线免费看| 国产 在线 视频 福利| 在线看片av以及毛片| 91精品国产麻豆福利在线| 日本青青草三级在线| 人人人爽人人澡人人高潮| 粉嫩av懂色av蜜臀av熟妇| 欧美最猛黑人XXXX黑人表情| 卡一卡二卡三永久榴莲视频| 国产精品V无码A片在线看小说| 色情毛片AAAAAA片毛片| 国产一卡2卡3卡四卡精品| 精品国产自在97香蕉| 强奷乱码欧妇女中文字幕熟女 | 无码免费人妻A片AAA毛片一区| XXX波多野结衣苍井空| 成人午夜特黄AAAAA片男男| 宅男在线永久免费观看网直播| 久久久国产精品免费A片蜜芽广| 久久99久久99精品| 内射精品无码中文字幕| 日本无码毛片一区二区手机看| 国产亚洲精品自在久久77婷婷| 狠狠噜天天噜日日噜久久久电影| 精品卡一卡二乱码新区| 少妇被又大又粗又爽毛片久久黑人| 丰满熟女人妻一区二区三| 日本高清一区免费中文视频| 国产成a人片在线观看视频99 | 国产高清精品丝瓜| 国产欧美精品一区二区三区-老狼| 久久99精品国产麻豆婷婷洗澡| 国产精品青青在线麻豆| 青青在线久青草免费观看| VA在线看国产免费| 最近最新MV中文字幕国语免费| 色欲AV在线观看国产精品| 日韩18视频在线观看| 人妻熟女一二三区夜夜爱| 成年美女黄网站色大免费全看| 无套内内射视频网站| 丁香花在线视频观看免费| 性一乱一交一A片视频| 亚洲?V中文字幕无码久久| 免费无码无套内谢软件| A阿V天堂免费无码专区| 黑人强辱丰满的人妻熟女| 亚洲有码亚洲无码| 福利姬液液酱高潮喷水白浆| 国产妇精品伦一这二区三| 在线无码专区系列| 中文精品卡1卡二卡3卡四卡| 浮妇高潮喷白浆视频 | 天仙TV萌白酱女仆喷水视频| 成人做爰A片免费播放| 精品国产91乱码一区二区三区| 成人午夜做爰高潮片免费吸气| 最爽最刺激18禁视频| 狠狠噜天天噜日日噜久久久电影 | 和老外3p爽粗大免费视频| 91精品久久久久久综合五月天| 午夜天堂AV久久久噜噜噜| 亚洲一区二区三区四区五区黄| 成年奭片免费观看大全部视频在线 | 91精品国产闺蜜国产| 污污内射久久一区二区欧美日韩| 成人亚洲一区二区色情无码潘金莲| AV免费网站在线观看| 1区2区3区4区产品乱码99| 国产ZLJZLJZLJZLJ| 又硬又粗进去好爽A片天美APP| 国产精选免费视频| 国产免费中文字幕?v在线| 免费吻胸抓胸激烈视频网站| 麻花传剧MV在线看高清美好生活| 果冻传媒色AV国产播放| 成人无码www免费视频网站软件| www.xxx-av.com| 扒开双腿被两个男人玩弄视频| 麻豆一区区三区四区产品麻豆| 波多野结衣一级婬片A片免费下载 欧一美一性一交一免一费一H一D 爽爽精品DVD蜜桃成熟时电影院 | 日韩久久久久久综合免费| 伊人网精品视频在线播放| 精品国产91乱码一区二区三区| 日韩欧美成人免费中文字幕| 国产AV亚洲精品久久久久久小说| 好诱人的搜子好爽免费观看| 直接看的成人无码视频网站| 最新女人另类ZOOZ0| 小sao贷大ji巴cao死你| 国产重口老太和小伙A片| 黄色大片久久毛片| 国产国语特级 a毛片| Japanese熟妇AV一区二区| 美女视频黄a视频全免费网站色窝| 欧美大尺BBXX黄A片| 深田咏美不戴胸罩邻居在线| 91久久人澡人人添人人爽| 69精品国产久热在线观看| 欧美性猛交xxx大交| 福利一区三区国产在线视频| 看国产一级特黄大片在线一| 日本一卡二卡3卡四卡网站精品| 2018国产精华国产精品| 1000部免费视频观看| 又大又粗又爽18禁免费看| 久久九九日本韩国精品| 国产av一区二区三区 精品| 免费看999永久A片视频| 亚洲成年人网站XXXX09| 国产人妻精品久久久久野外| 亚洲亚洲国产精品| 国产亚洲精品久久久999苍井空| 爆乳JUFD492汗だく肉感| 欧美人与动牲交ZOOZ乌克兰| 久久亚洲综合精品国产99| 精品麻豆剧传媒AV国产| 国产精选莉莉私人影院| 人妻无码AV中文字久久| 欧美亚洲国产手机在线有码| 人间天堂视频在线看| 女人18毛片a级毛片| 国产成人无码精品久久久影院| 色诱视频网站免费观看| 狠狠躁日日躁夜夜躁A片55| 日韩少妇人妻喷潮湿无码视频| 四川女人毛多水多A片| (凹凸)最新毛片婷婷99精品视频| 中文字幕A片视频一区二区| XUNLEIGE在线观看| 久久午夜一区二区| 色情免费网址直接观看| 人妻含泪让粗大挺进| 亚洲极美女高清视频| 国产乱人对白A片麻豆| 国产又色又爽又刺激的A片| H嗯啊高潮抽搐A片视频欧美| WWW国产亚洲精品久久| 福利姬国产精品一区在线观看| 国产日韩精品v欧美一区二区三区| 小明日韩在线看看永久区域| japanesevideo喷潮| 国产与子敌伦孑xXⅩ| 中国日本韩国免费观看视频| www.3344日本午夜福利| 扒开双腿粉嫩流白浆视频| 无套内谢大学生A片| 日本熟妇乱人伦A片一区| 亚洲精品久久久WWW小说| 欧美国产日韩在线| WWW色视频片内射| 国产成熟妇人高潮A片| 无码人妻久久一区二区三区蜜桃 | IJZZIJZZIJZZ教师水多| 在线中文av观看网站免费| 日本特黄群交A片视频| 高挑人妻无奈张开腿| 先锋影音av亚洲一区二区| 亚洲精品国产日韩成| (愛妃視頻)欧美日韩国产这里只有精品| 终极蜘蛛侠动画片全集| 着衣爆乳揉みま痴汉电车中文字幕| 久久免费看少妇高潮A片小说图片| 日本久久久久久久中文字幕| 精品亚洲国产成人A片在线观看| 免费又黄又爽又色的绿巨人| 亚洲av无码专区亚洲av影音先锋| 99国内偷揿国产精品人妻| 国产日韩?v免费观看| 日本黄A级A片国产免费| 亚洲 日本 欧洲 欧美 视频 | 人妻少妇精品无码一区二区三区| 免费网站黄页4188| 在线中文av观看网站免费| 强奷乱码欧妇女中文字幕熟女| 国产AA久久大片日本无码| 99精品免费久久久久久久久日本| 国产男人午夜视频在线观看 | a v 在线视频 亚洲免费| 国产亚洲成AV人片在线观黄桃 | 秋霞电影网院午夜伦不卡A片| 青青草av国产精品| 欧美激情一区二区三级高清视频 | 色妞AV永久一区二区国产AV开| 夜夜爽妓女8888视频免费观看| 麻豆精产国品一二三产| 欧美叉叉叉BBB网站| 免费观看成人毛片A片2008| 丰满少妇啪啪呻吟69XX| 日本道专区无码中文字幕| 麻豆传媒app官网下载安装| H嗯啊高潮抽搐A片视频欧美 | 2018一本到国产手机在线| 蜜臀av性久久久久蜜臀aⅴ流畅| 久久久久久久久66精品片| 国产高潮流白浆视频| 无套内射GIF舔B吃奶| 一夜七次郎免费线路www2| 欧美中文字幕一区二区三区老色批| PORN国产最新91| 精品人妻少妇一区二区三区| 国产精品扒开腿做爽爽爽视频| 一本大道香蕉在线资源| 国产成年大片免费视频播放| 国产影视无码久久| 狠狠色丁香久久婷婷综合图片| 女人被添全过程A片试看V| 成年人免费网站视频| 国产呦精品一区二区三区下载| 日本丰满熟妇被捏出奶水| 亚洲 小说 欧美 中文 在线| 色婷婷色综合缴情网站| 免费无人区男男码卡二卡| 国产免费无码成人A片在线观看| 午夜成人理论片A片AAA图片| 日本黄色免费一级片| 最近中文字幕MV在线2018| 欧美大尺度无遮挡A片杏仁 | 亚洲AV无码A片一二三区| 日本道专区无码中文字幕| 久久久精品理论A级A片| 中日韩一卡二卡三卡四卡免| 免费无码婬片AAAA片软件| 欧美国产日韩一区二区| 免费无码无套内谢软件| 两女隔帘按摩被高潮在线观看| 精品乱码卡1卡2卡3免费下载| 女人在厨房被添高潮全过程A片 | 人妻无码手机在线中文| 欧美性A片又大又长| 小明日韩在线看看永久区域| 成年人视频日本大香蕉久久| 成年人精品免费视频| 中文精品卡1卡二卡3卡四卡| 国产SUV精品一区二区6| a级毛片黄免费a级毛片| 久久亚洲精品AV成人无| 精品乱码一二三四区别| 日本1卡2卡3卡4卡| 97久久超碰中文字幕| 国产欧美日韩直播在线| 91高潮一级视频免费观看| 久久久这里只有精品加勒比| 国产在视频视频2019| 2023国精产品一二二线免费| 欧美叉叉叉BBB网站| 成片一卡三卡四卡免费网站| 2019年92午夜视频福利| sao虎视频在线网址最新| 亚洲 欧美 国产 另类卡通| 成人片一级A片免费视频| 亚洲国产精品一区二区玖玖| 91在线精品亚洲第一区香蕉| 男女一边摸一边做爽爽的免费文字 | 影音先锋看波波片资源| 少妇伦子伦精品无码| 国产人妻人伦精品无码.麻豆| 91亚洲精品五月天| 麻豆乱码一卡二卡三卡视频| 五月综合激情婷婷六月色窝| 污到你湿的动态图片gif| 成人a∨专区精品无码国产| 看看少妇的阳道毛偷拍女浴室| 五月香六月婷婷激情综合| 久久久精品人妻一二三区无码蜜臀| 成人亚洲精品久久久久| 国产精品久久久久一区二区三区共| 四川少妇WBB槡BBBB搡BBBB| 在线视频免费观看爽爽爽| 按摩做爰A片在线播放| 亚洲综合日韩欧美一区二区| 肉浦团在线观看快播| 日韩精品色情AV无码一区| 国产精品成人无码A片免费网址| 一级特黄aa大片欧美| 亚洲欧洲日产国码韩国| 亚洲精品无码久久久久苍井空国产| 1000部又爽又黄无遮挡的视频| 玩弄丰满少妇XXXXX性多毛| 日韩一级精品久久久久| 成人做爰片免费网站| 成品片a免人看免费| GOGO人体做爰AAAA免费| 亚洲国产货青视觉盛宴| 粗大猛烈进出身体高潮视频| 两男一女60分钟视频| 91免费精品国产拍在线| 人妻夜夜爽天天爽三区麻豆AV网站| 日产一卡2卡三卡乱码在线下载| 高清无码视频免费观看| 日韩一卡2卡3卡4卡乱码免费| 中文 在线 日韩 亚洲 欧美| 超碰国产人人添人人喊| 美女国产欧美日韩| 国产成人久久精品AV| 麻豆国产人妻欲求不满谁演的| 午夜中国女人性在线| 国产1卡二卡3卡四卡乱码| 精品人妻少妇一区二区三区| 欧美成人午夜精品久久久| 91美女精品视频 国产| 国产一卡2卡3卡4卡无卡免费网站| 亚洲高清国产拍精品动图| AV国産精品毛片一区二区三区| 美女国产欧美日韩| 国产日韩精品亚洲图片自拍| 国产精品国产三级国AV在线观看| 精品久久久久久久久久久久| 亚洲精品久久7777777| 乐播AV永久无码精品一区二区 | 国产成人精品久久一区三级| 成年人免费看的视频| 中文字幕人妻二区| 色综合久久88色综合天天6| 国产精品99久久久久久久女警| 无码激情AAAAA片-区区| 北条麻妃视频在线| 成人91老师午夜精品啪| 亚洲精品AV无码喷奶水糖心| 激烈娇喘叫1V1高H校园视频| 19不插片免费视频| a级av电影在线观看| 亚洲人美女肛交真人全程| 极品JK小仙女自慰喷水牛牛影视| 亚洲最大的熟女水蜜桃AV网站 | 一区二区三区国产| 国产在线观看91香蕉| 久久久国产精品人人片| 国产高清在线精品一区_久| 欧美日韩永久久一区二区三区| 扒开双腿疯狂进出喷水高潮| 久久久久高清视频中文字幕 | 最近更新中文字幕2019国语1| 一线免费视频BD高清| 性按摩玩人妻HD中文字幕| 亚洲精品成人无码A片在线| 免费又黄又爽A片免费看| 成人亚洲A片V一区二区三区蜜月| 日韩二丶三区视频免费| 2015av天堂影音先锋| 国产精品成人无码A片免费软件| 女人色国产a精品| HEZYO加勒比久久爱综合| 免费区大尺码体验区| 一女被二男吃奶A片视频| VA在线看国产免费| 亚洲精品久久久久久动漫| 美女网站在线观看视频18| 久久久久久久综合狠狠综合| 97精品视频在线观看0| 午夜影院免费试看五分钟| 亚洲国产成人免会观看| av天堂天堂久久久av不卡| 日韩国产成人无码AV毛片蜜柚| 国产麻豆一级在线观看| 日韩少妇成熟A片无码专区| 亚洲精品久久久久久中女字幕| 成人国产三级视频在线观看| 色欲AV亚洲情无码AV蜜桃| 7777色鬼XXXX欧美色妇 | 欧美人zoxxxx另类| 欧美一级淫荡免费观看| 久久午夜夜伦鲁鲁片无码免费| 91视频国产一区| 玩弄放荡人妻一区二区三区| 免费吻胸抓胸激烈视频网站| 欧美中文字幕有码无码| 亚洲春色中文字幕久久久-三上亚 2018一本到国产手机在线 | 久久视频在线视频观看99| 无码国产伦一区二区三区视频| av网站免费线看精品| 少妇寂寞被按摩师| 国产女人夜夜春夜夜爽免费看| 国产精品99久久久久久久女警| 国精品午夜福利视频不卡麻豆| 亚洲国产精品无码久久久久久久久| 亚洲AV久久无码精品九九九小说| 乳荡麻麻肉欲500合集| 成人无码区免费A片视频WWW | 97高清国语自产拍久久| 人妻丰满熟妇av无码区乱| 成人a∨专区精品无码国产| 国产精品成人一区二区无码久久| 中国日本韩国免费观看视频| 国产不卡一区二区免费视频| 老女人与小伙子露脸对白| 人妻丰满熟妇av无码区乱| 免费毛片网站在线观看| 午夜中国女人性在线| 最近中文字幕mv第三季歌词| 蜜桃视频成人A片免费观看| 亚洲A片成人无码久久精品青桔| AV天堂午夜精品一区二区三区| 娇妻被粗大JIB捣出了白浆视频 | 日本公与妇仑乱免费无码| 顶级少妇高潮销魂抽搐| 国精产品999一区二区三区有限| 91麻豆乱码国产一区二区三区| 无码人妻精品一区二区三区色欲 | 香蕉视频免费版在线高清全集 | 精品日韩一卡2卡三卡4卡乱码 | 久久亚洲综合精品国产99| 亚洲A片永久无码精品| 欧美AAAAAABBBBB| 日韩激情小说一区二区| 无码激情AAAAA片-区区| 中文字幕一区二区区免| 日韩精品色情AV无码一区| FREECHINESE东北女人真爽| 在线视频免费观看爽爽爽| 少妇被又大又粗又爽毛片欧美一| 少妇做爰免费理伦电影| 国产美女在线精品观看福利| 无码精品一区二区三区在线A片| 无码精品人妻一区二区三区寡妇| 欧美性猛交99久久久久99按摩| 亚洲精品无码成人A片在线虐C| 亚洲AV日韩AV不卡四虎| 四川BBBBBB搡BBB搡BBBB| 国产人妻人伦AV又粗又大| 国产精品色欲AV亚洲三区软件| 国产又黄又爽又刺激的免费网址| 日本高清2018字幕| 草莓视频下载成人| 在线无码专区系列| 久久精品成人一区二区三区蜜臀| 久久tv中文字幕首页| 青青草原精品国产亚洲AV| www国产亚洲精品久久网站| 精品夜夜爽欧美毛片视频| 亚洲A片无码成人精品区| 娇妻被粗大JIB捣出了白浆视频| 岛国av一区二区精品| 国产成人无码精品久久久性色| 亚洲精品久久片久久久久| 影888午夜理论不卡| 美女好紧好大好爽12p| 狠狠噜天天噜日日噜久久久电影| 国产精品亚洲天堂2021| 韩国免费理论片A级奶大| 高清无码中文字幕影片| 午夜肉体高潮免费毛片| 色婷婷欧美在线播放内射| 西西4444www大胆无码| 午夜福利不卡在线视频| 欧美性爱中文字幕无线码| 国产精品亚洲综合一区二区三区| 人妻av中文字幕 -迅雷| 男女激情无遮挡免费视频| 吃奶呻吟打开双腿做受是免费视频| 欧美产品与亚洲日韩视频| 国产精品嫩草久久久久| 亚洲国产精品无码久久久久久久久| 欧一欧二欧三精品| 日本无人区码一码二码三码四码| 绯色av一区二区三区在线观看| 浮妇高潮喷白浆视频| 啊轻点灬大JI巴太粗A片| 国产亚洲精品久久7788| 国产AV99激情久久无码天堂| 久久精品熟女亚洲国产..| 亚洲男人片片在线观看| 日本高清二区视频| 国产精品 同事 在线 视频 | 麻豆产国品一二三产品区别| 扒开双腿疯狂进出喷水高潮| 年轻的妺妺伦理HD中文| 成人电影在线观看热| 成人免费A片XxX视频流奶| 日本人妻伦在线中文字幕| 精品国产乱码久久久久久小说| 男女性杂交内射妇女BBWXZ| 狠狠色综合7777久夜色撩人| 中文字幕亚洲欧美日韩2019| AV国産精品毛片一区二区三区| 欧洲亚洲精品A片久久99果冻| 97在线看午夜福利| 国产男女猛烈无遮挡A片小说| 国产裸体精品免费观看| 无码人妻丰满熟妇A片护士M| 无码国产精品成人午夜视频| 韩国无遮挡无码国产天堂久久天 | 麻豆国产96在线日韩麻豆| 1区2区3区4区产品乱码99 | 一本道东京无码dvd| 国产成人AV在线免播放观看新| 麻豆国产精品色欲AV亚洲三区| 成人性生交A片免费直播软件| 按摩性高湖婬AAA片A片中国 | 日本人妻中文字幕有码在线视频观看视频| 亚洲极美女高清视频| 免费人成视频X8X8入口观看大| 双腿扒开调教羞辱奶头| 老司机求福利网址2017| 亚洲欧美日韩自慰一区 | 国产精品亚洲天堂2021| 四川少妇WBB槡BBBB搡BBBB| 亚洲A片永久无码精品| 精品国产91乱码一区二区三区| 亚洲日本一区二区一本一道| 欧美白人极品性喷潮| 97在线看午夜福利| 亚洲最大自拍一级婬片| 动漫AV网站免费观看| 久久久久久九九97精品中文无码| HEYZO无码中文字幕人妻| 一夜七次郎免费线路www2| 巜隔壁的人妻2伦丰满| 91高潮一级视频免费观看| 国产精品色欲AV亚洲三区软件| 少妇人妻偷人精品无码91动漫| 无套内谢大学生A片| av大片在线网站| 91久久精品一区二区别| 疯狂揉吮少妇嫩草99AV小说| 亚洲视频在线观看..| 特黄少妇无码AA级毛片| 2023国精产品一二二线免费| 园产一级A爱看全免费观看| heyzo大桥未久持续中出| 免费无码又爽又刺激A片软| 精品久久久久久国产| 91精品中文字幕一区二区三区 | 久久久乱码精品亚洲日韩| 欧美中文字幕一区二区三区老色批 | 中文字幕一区中文亚洲| 国产内射老熟女AAAA| 欧美 亚洲 另类 偷偷 自拍| 午夜精品国产精品大乳美女| 91中文字幕国产| 中文字幕人妻丰满熟女| jk制服白丝袜看内内18禁|